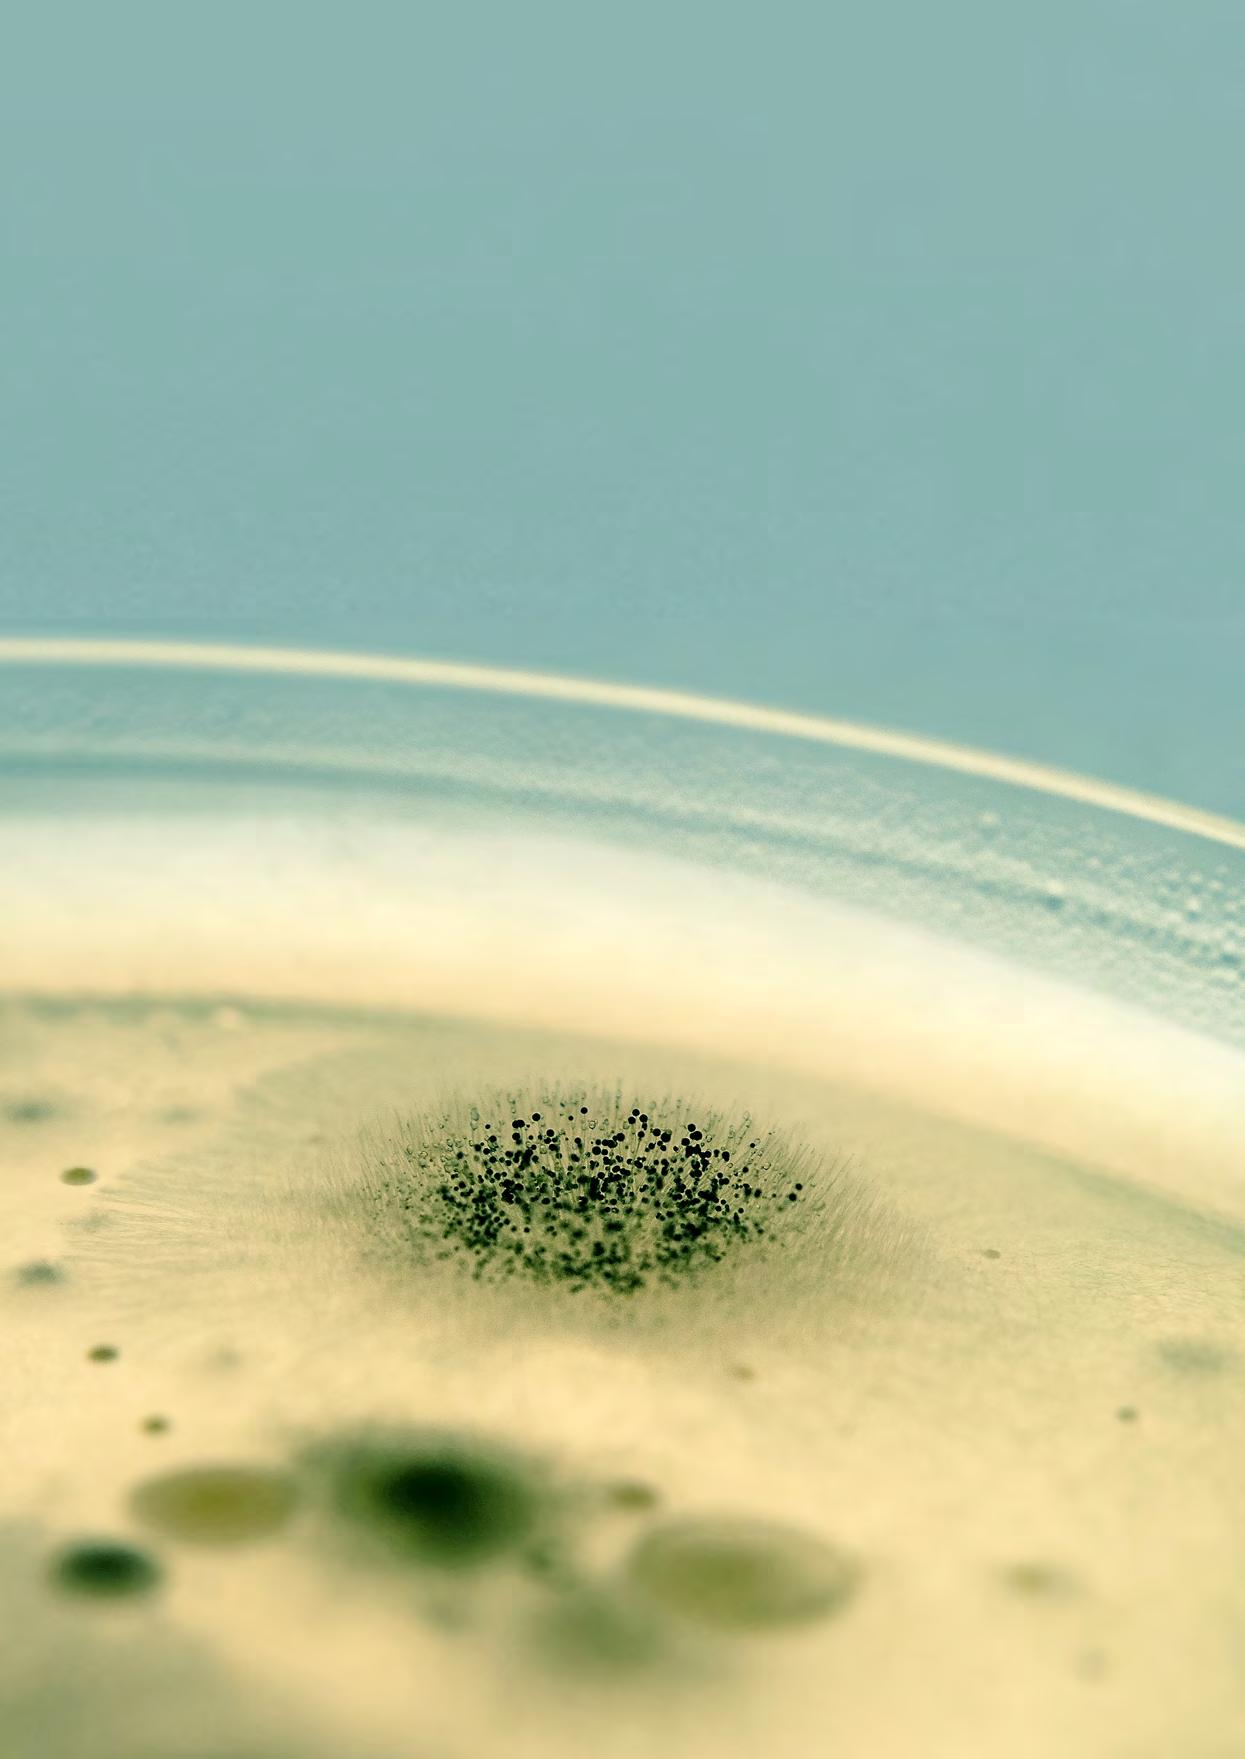

Act to inspire & Inspire to act Progress Report 2025
This is Axfoundation
and our ecosystem, as we operate at the beginning of 2025. Founded in 1993 by Antonia Ax:son Johnson, Axfoundation is an independent, non-profit organization. We work hands-on to accelerate innovative solutions in two program areas: Future Food and Future Materials. Axfoundation’s center for sustainable solutions is Torsåker Farm, north of Stockholm.
Together with partners from diverse fields and disciplines, we address local and global sustainability challenges, focusing on practical issues related to the food we eat and the resources we use. This report presents the results and impacts of our work during 2023 and 2024.
23
Businesses
Sustainable agriculture
Civil society
We run more than 30 projects within the areas of Future Food and Future Materials.
work at Axfoundation’s office in Stockholm and at Torsåker Farm. passionate colleagues
Sectors and actors
Public sector
15 industries
Our current projects span 15 industries including agriculture, energy, textiles, waste management, fishing, food, and technology.
Trade unions
We believe strongly in business as a driving force for change.
Practitioners
Sustainable use of resources
Our projects engage sustainability professionals, entrepreneurs, researchers, primary producers, innovators, policymakers, practitioners, and executives.
Accelerators and incubators
Axfoundation bridges researchers and practitioners, collaborating with over 100 researchers to address complex issues related to food and materials.
Axfoundation collaborates across sectors with more than
300 partners
153 Companies, 39 Accelerators and Foundations, 23 Industry associations, 28 Academic institutions, 12 Governmental institutions, 10 Civil Society Organizations, 8 Networks, and 4 Trade unions.
The Material Shift
Circular Transition


This report is produced by Axfoundation 2025
Text & Design: Viveka Risberg
Photos & Illustrations: See p. 79
Layout Assistance: Pelle Jansson
Cover Concept: Linda Andersson
Proofreading: Minna Berg
Responsible Publisher: Maria Smith



The Art of Doing and Adapting to the New
Can acting to inspire be an act of resistance? Yes, against indifference, panic, and the feeling of helplessness. That’s the view of Axfoundation’s Chair, Alexandra Mörner, who, along with founder Antonia Ax:son Johnson, represents the fifth and fourth generations, respectively, of a family of entrepreneurs. Both believe it as crucial to work on all fronts for sustainable development and a better world.

We live in a time when humanity’s impact on the planet’s life-supporting systems has pushed us far beyond our safe operating space on Earth, leaving many paralyzed by a sense of hopelessness. Not everyone has the resources, capacity, or ability to do something about the state of the world. And, as we know, no one can do everything alone. But many can contribute, and these contributions can take different forms.
For Axfoundation, that contribution consists of practical, concrete actions – showing the way by developing solutions. The goal is for these solutions to inspire, be scaled
up, and contribute to long-term sustainable development in society. Consequently, the motto “Act to Inspire – Inspire to Act” is very much alive on a daily basis. Alexandra Mörner, Chair of Axfoundation, reflects on why it is so important.
– My personal philosophy in life is that it’s up to each individual to make the best of the circumstances they have, whether it’s financial resources or personal abilities. Most of all, I think about everyone’s responsibility to use their own strengths and gifts to make the world a better place, says Alexandra.
It’s no coincidence, then, that Axfoundation is characterized by a wide range of expertise. Here, farmers, sensory experts, behavioral scientists, business developers, chefs, social scientists, biologists, political scientists, and food experts all work together. This mix of abilities and perspectives is the superpower that defines Axfoundation – driving action and attracting collaborators from various fields and sectors.
Axfoundation was founded in 1993 as a result of Antonia Ax:son Johnson’s growing frustration and her belief that business is not just about maximizing profit. Instead, she was driven by the conviction that businesses should be a positive force for change in society. This idea was met with great skepticism by many in the business world in the 1990s – but time has since caught up.
Today, Antonia’s long-standing contributions to sustainable development and societal benefit have resulted in numerous international recognitions and honorary awards. In the fall of 2024, Antonia was named an honorary doctor at the Swedish University of Agricultural Sciences. In her keynote speech, she explained her credo:
– A ‘good company’ is the greatest force for change in society. With the reach companies have, they can influence people in a way that far exceeds the power of politicians, authorities, and even the church.
For the first 20 years, Axfoundation channeled financial resources into
environmental research. Gradually, a new strategy emerged, rooted in the ability to adapt and the sense of urgency in a world facing major challenges on all fronts.
– Making a difference where you are became a guiding principle for us. To concretely and practically show that there are solutions, that something can be done, and to inspire others – this became Axfoundation’s guiding star and motto. That’s why we call ourselves a dotank, says Antonia.
The motto has materialized in the practical work that defines Torsåker Farm today, Axfoundation’s development center. Here, theory is transformed into practice, and it’s all about walking the talk in everything that’s presented, done, and served. Many partners

“To show that there are solutions, and to inspire others –this became Axfoundation's guiding star and motto.”
Antonia Ax:son Johnson, Founder
and visitors testify that it’s inspiring to see the solution on the plate or to hold a circular material in their hands.
But it can also be surprising that what is clearly possible hasn’t already become widely accepted, commercialized, and the norm in society. The slow pace of transition is largely due to various barriers to scaling innovative solutions. Sometimes, challenging these barriers becomes an uncomfortable task, and that’s where the effort must be focused, according to Alexandra:
– The way we work is not business as usual. We want to show the way forward, and that means challenging entrenched structures, behaviors, and outdated regulations. To drive change, we have to work on all fronts. We are a resistance movement against indifference, paralysis, and bureaucratic stagnation.
The world is changing rapidly and is under immense pressure. Several systemic shifts need to happen in parallel, and it’s essential
to be both agile and forward-thinking. The ability to adapt to the current situation and think creatively is second nature to Antonia and Alexandra:
– As a family of entrepreneurs, we have a strong sense of long-term thinking and entrepreneurship, and perhaps most importantly – adaptation. It’s about being able to think long-term while also being capable of renewal. In this, our family’s entrepreneurial spirit is a great asset.
Alexandra feels a great sense of responsibility and humility in the task of always looking ahead and striving to do things that, in the hands of Axfoundation or others, lead to change and inspiration. Part of trying also means sometimes failing, when solutions, for various reasons, never take off. In those cases, it’s important to view ‘failure’ from a learning perspective.
This report highlights a couple of such ‘Courage to fail’ examples, one of which is about the hemp cultivation at Torsåker Farm


“We are a resistance movement against indifference, paralysis, and bureaucratic stagnation.”
Alexandra Mörner, Chair of the Board
that didn’t go as expected. The field of threemeter-high fiber hemp had raised suspicions among passersby, and one late Sunday evening in the spring of 2023, Antonia received an unexpected visit.
– A police car drove onto my house. I was, of course, nervous and wondered what had happened. Four officers stepped out of the car holding up a plant. They said I had been reported for growing hemp. I replied that it was industrial hemp, which can be used in textiles and food. They just stared at me at first but admitted that it didn’t smell like they expected, Antonia recalls with amusement.
Antonia and Alexandra still laugh about the
incident. The lesson learned was to put up informational signs around the hemp field to prevent further misunderstandings. Most of the projects, however, are thriving, and Antonia’s early dream of a nonprofit focused on sustainability, which evolved into the do-tank Axfoundation, is delivering results beyond her expectations.
– There is such incredible power in all these collaborations, and at Torsåker Farm, we can show in concrete terms how we can make the planet a little more sustainable. We have impatient, knowledgeable, and driven employees who possess both imagination and the power to execute. It’s as if my wildest fantasies and dreams have come true, concludes Antonia.
“The opportunities and solutions often arise through collaboration.”
Maria Smith, Secretary-General, Axfoundation

Power to the People –and our Partners
The most important asset at Axfoundation is the people who work here. Since 2022, the team has more than doubled in size and is now characterized by a powerful combination of skills and experiences. This dynamic resource, together with our collaborating partners from academia, businesses, and other sectors, creates an immense force for change.
A reflection of the outcome is found in this Progress report, covering our progress during 2023–2024.
At Axfoundation, we are not interested in projects that fizzle out like “tomtebloss” –sparklers in Swedish. Instead, we focus on creating lasting change through impactful solutions and collaborations.
We aim to go beyond incremental improvements and focus on solutions that address the root causes of today’s sustainability challenges. The opportunities and solutions often arise through collaboration.
Our working model
Grounded in the latest research, the work engages a diverse range of actors and follows an iterative process. From a multitude of ideas, only a select few advance to the project phase, with the goal of achieving scalable and transformative societal change.
6 Lessons learned The project is analyzed, and effects measured.
5 Scaling up and dissemination
The pilot is scaled up to an industry-wide collaboration.
4 Follow up and evaluation Results and future potential are evaluated.
Our two program areas, Future Food and Future Materials, frame our efforts to work practically and concretely towards building a sustainable society. We do it through more than 30 projects in collaboration with around 300 partners from academia, businesses, and organizations. We bring in our various areas of expertise and work hands-on in the projects, in collaboration with our partners. Typically, we gather representatives from the whole value chain to join our projects.
Our working model, shaped by years of successful and, to be honest, less successful projects, is central to how we approach this challenge. One aspect I find particularly important is the constant emphasis on being solution-focused and practical. Looking back
1 Identifying a challenge
Analyzing the problem and generating ideas.
This report uses symbols to indicate the stage of progress for each project.
2 Situational analysis
Practical solutions are investigated with a wide range of actors.
3 Pilot test Solutions are developed and tested on a smaller scale.
at our previous Progress report from 2023, it’s rewarding to see the progress we’ve made together with our partners.
Torsåker Farm is now established as Axfoundation’s development center for future food and materials. Here, we aim to accelerate the transition to sustainable materials and food systems – for the benefit of the climate, the environment, and public health.
Looking ahead, we have many exciting projects and collaborations on the horizon –and, of course, more sustainability problems to dig into. We are committed to understanding them at their core, to use our power and skills to develop transformative solutions with our partners.


“We
constantly ask ourselves: Is it tasty and nutritious? Do people want it? And will every step in this food chain be a good business? If yes, it can take off.”
Anna Henning Moberg, Head of Operations, Torsåker Farm
Torsåker Farm
A test hub for less talk and more action
Why are brownies being baked with blood in the test kitchen? What are wool and reed doing around the tomato plants? Why are researchers digging in the Kernza field? At Axfoundation’s center for sustainable solutions, experiments are underway to discover and test future food and materials.

Located about 30 kilometers north of Stockholm, Torsåker Farm is a vibrant hub for the Axfoundation team, as well as dedicated researchers and practitioners. Here, the goal is to demonstrate that the future holds food and material solutions that are delicious, simple, and sustainable.
Together with stakeholders across entire value chains and sectors, Axfoundation aims to accelerate the transition to green and circular systems, benefiting the climate,
the environment, and public health. While the program areas Future Food and Future Materials develop the ‘What’ – namely system shifts or pilot solutions – Torsåker Farm offers a unique opportunity for Axfoundation and its partners to get their hands dirty and answer the question ‘How’.
Whether it concerns farming, food, or materials, the outdoor surroundings and indoor facilities provide essential spaces for reality-checking project-based ideas. With

350 hectares of forest and agricultural land, along with the renovated barn featuring test kitchens, Torsåker Farm has become a key hub for leading experts and handson entrepreneurs to refine solutions for successful scale-up and viability.
The ongoing work at Torsåker Farm is characterized by teamwork and crosscutting collaboration. By bringing together people from the entire value chain – primary producers, suppliers, and retailers around the same table – several perspectives are considered and addressed.
Everything being done at Torsåker Farm is thoroughly grounded in the latest science.

Collaboration with researchers involves providing land and facilities for conducting research, which in turn contributes to projects. A brilliant idea must also be profitable, logistically viable, in demand, and affordable (and tasty as well as nutritious if it’s food) to withstand the ultimate test: reality.
Entrepreneurs, practitioners, and representatives from different parts of the ecosystem – who wouldn’t typically collaborate – come together to pursue a common goal: developing commercially viable solutions in the areas of future food and future materials. Each person’s contribution adds to the collective intelligence that drives Axfoundation’s engine.
“On our visit to Torsåker Farm, we gained inspiration for new ways of thinking and new insights into the country's food sector and the potential of collaborative efforts. Overall, it was a very rewarding experience, not least due to the warm reception from all the staff and the beautiful and pleasant environment.”
Åsa Persson, Chair of the Swedish Climate Policy Council, visited Torsåker Farm with the Council in September 2024.
Served on a walkand-talk lunch: Pizza made by kernza flour and toppings from the experimental garden.

Maria Smith presents Axfoundation's longstanding work on antibiotic resistance to the EU's agriculture ministers.





More nutrients for the money
Within the Future Food program, a method for estimating nutritional cost and nutritional value has been developed using the concept of nutrient density as base. Here is the top five list of the most and least nutritious foods for the money when it comes to common Swedish foods:
Top Five
The most nutrients for the money
1. Liver
2. Sunflower seeds
3. Carrot

4. Frozen brussel sprouts & broccoli
5. Rutabaga


Bottom Five
The least nutrients for the money
1. Bacon
2. Whipping cream
3. Chorizo
4. Dried cranberries
5. Crème fraîche

”It was exciting and educational to learn about the innovative projects at Torsåker Farm. My EU ministerial colleagues and I particularly appreciated visiting the experimental garden and tasting the flavors on site. It's an inspiring facility where the future of food production is being shaped.”
Peter Kullgren, Sweden’s Minister for Rural Affairs, visited Torsåker Farm with his EU counterparts in June 2023.


Innovation support for sustainable solutions
At Torsåker Farm, Axfoundation offers practical innovation support to entrepreneurs and researchers who want to further develop innovative, transformative solutions within sustainable food systems or related areas. A prerequisite for the support is that the innovation has the potential to positively contribute to a more sustainable society, locally and globally.
In the fields
Torsåker Farm encompasses fields, meadows, and woodlands dedicated to open-field cultivation. At the farm, sustainable farming and aquaculture methods are evaluated, both traditional and innovative crops are tested for food and bio-based materials, and waste streams are identified to develop circular solutions. Several research projects, some spanning multiple years, are conducted at the farm, bringing researchers to the site daily. Every effort is made to support and facilitate their work.
Inside the facilities
Ladugården (the Barn) is Axfoundation’s innovation arena with 1,000 square meters of kitchen space providing practical support for researchers and entrepreneurs. It’s also an essential place for Axfoundation’s own projects. The Barn contains four test kitchens, a restaurant kitchen, a bakery and packaging facilities. Here is where new ingredients and food products are tested and developed in connection to the projects, and in collaboration with partners.


In the experminental garden Axfoundation operates an experimental garden at Torsåker Farm, ideal for openfield cultivation. Various sustainable fertilizers and horticulture methods are being tested, while vegetables are assessed for their gastronomical potential and ability to thrive in a changing climate. Bio-based materials, such as wool and harvested reeds, are also evaluated as soil improvers and compost materials.

EAT Lancet on the Plate
One of Axfoundation’s missions is to translate the EAT-Lancet principles into action on the plate. Essential prerequisites in this job are sustainability, nutrition, culinary excellence, and economy. In other words, the food or the meal needs to be sustainable, healthy, tasty, and affordable. In the end, it also needs to be wanted, by businesses and consumers. Therefore, behaviors are also important aspects to consider in our work.
Meet our partner
Dr. Max Troell, Associate Professor at Stockholm Resilience Centre, Program Director and Senior Researcher at the Royal Swedish Academy of Sciences, Program director of Sustainable Seafood Program at Beijer Institute and member of the Science Team in SeaBOS.

– Torsåker Farm has been serving as a very appreciated platform for communicating about the unique collaboration between global seafood leaders and science within SeaBOS. Aiming for transformative change and improved stewardship within the seafood industry is much in line with the philosophy behind the work at Torsåker Farm. Connecting SeaBOS' leaders with Torsåker Farm's sustainability portfolio, including circularity and efficient resource use in seafood production, has provided positive injections to their efforts.
In what ways can a place like Torsåker Farm contribute to research in general, and to researchers in their daily work, by demonstrating practical application?
– I would argue that the main strength of Torsåker Farm is the people that work there – being so enthusiastic and committed to make real change happen. Their ability to take on and test ideas is impressive and their ambitions to gain a full systems understanding is fundamental for any success. Torsåker Farm’s large network consisting of a diversity of stakeholders enables scientists to connect to relevant groups in ways that otherwise would be difficult.

Timeline Torsåker Farm
500 BCE to around 1050 CE
A ncient remains indicate historical settlement with agriculture and livestock farming dating back to the Iron Age. The area has medieval layers and remnants of a farming village known as Tjursåker, which belonged to Skokloster until 1328.
1348 The first recorded mention of Torsåker, then called Tjursåker.
1600s The estate was owned by several noble barons, members of the council, and courtiers, among others
1700s Torsåker had its heyday with farmland, ponds, livestock, and daily sales in Stockholm, traces of which can still be seen in the remnants of an English-style park surrounding the estate.
1700s Countess Gyllenborg had a barn built for 80 cows and eight horses. In the late 1700s, Jacob Johan Anckarström was active at Torsåker and was considered a highly innovative farmer.
1800s After a period of decline, a new era of prosperity was created in the late 1800s, with expanded agriculture.
1872 Torsåker Manor was built.
1900s After a decline around WWI, agriculture expanded in the mid-century.
1965 The barn burned down. Following the fire, the barn was rebuilt as a modern hall building, with the original brick and stone walls preserved.
1982 A building inventory deemed Torsåker's old barn to be of no cultural or historical interest.






























2010 The Ax:son Johnson family purchased Torsåker.
2017 Axfoundation broke ground on the farm and, with the help of tenant farmer Mats Eriksson, sowed the legumes that, after processing, became Swedish Legume Mince (Svenskodlad färs).
2017 The experimental garden was established with the Nordic genebank, with 100 square meters of cultivation.
2018 The Ax:son Johnson family decided to renovate the old barn and, together with Axfoundation, develop a center for the food of the future.
2022 The first seafood product from Torsåker Farm was launched – a fish cake made from bycatch bream



and Swedish legumes, with the entire production process taking place in Sweden.
2022 At the Human Nature seminar, the Barn was inaugurated to the sounds of “kulning”, a traditional Nordic singing technique.
2023 A delegation of Agriculture Ministers from the European Union visited Torsåker Farm, led by Swedish Minister Peter Kullgren.
2024 Torsåker Farm expands its activities to include future materials, becoming Axfoundation’s center for sustainable solutions. The cultivation area in the experimental garden now covered 600 square meters. Visits by The Swedish Climate Policy Council, and Global Leaders Group om AMR.




Future Food

Axfoundation’s Program area that develops commercially viable solutions for sustainable food systems.

We Cannot Stop Eating
Of all the challenges humanity faces, food, climate, and the alarming decline of biodiversity are the most urgent. Shifting our food systems is not optional; it’s essential for the future of humanity and a thriving planet.
A significant decline in global biodiversity continues, with an average 73% reduction in wildlife populations from 1970 to 2020. This alarming trend is linked to unsustainable agricultural practices and land use.
Also, severe challenges are facing the world’s oceans, impacted by climate change and other environmental stressors. The degradation of marine ecosystems has led to declines in various fish populations and the overall health of marine habitats.
Lastly, six out of the nine planetary boundaries have been breached, indicating that the Earth is under increasing stress. The state of these boundaries suggests that we
are moving beyond the safe operating space necessary for a stable planet.
At Axfoundation, the program area Future Food contributes to hinder the destructive systemic changes by four system corrections for an overall sustainable, global food system. These four system corrections constitute the framework of our work:
1. From Feed to Food
When our food eats our food, it’s far from resource-efficient. Today, food-grade products are often directed straight to animal feed without being evaluated for human consumption first. More than 75% of the wildcaught Swedish fish goes to feed.
“In theory, we can stop flying and buying things, but we can never stop eating. Since food systems significantly contribute to all the environmental challenges we are in, they must be fixed now.”
Madeleine Linins Mörner, Programme Director, Future Food
2. Anatomical Responsibility
We eat the eggs, but we don't eat the laying hen. We eat the roe, but not the vendace. Additionally, we only consume parts of the product that eventually ends up on the plate, resulting in large losses throughout the food chain. We must make use of what we already have before we talk about producing more.
3. Nutrition Yield
Today, the goal is to get as much volume as possible, whether it’s wheat in the field or food in your shopping cart. But we don’t need volume; we need nutrition. That’s why 'nutrition yield' is a smarter measure.
4. From Depleting to Nourishing
Most of what we eat has depleted ecosystems during its production, making them worse off. But there are species, cultivation systems, and processes that can instead nourish our ecosystems and help sustain them over time. These need to be utilized and developed.
Four goals and collaborative work
To contribute to these system corrections, we have set up four goals that our projects should help achieve: Sustainable agriculture, Sustainable seafood, Sustainable use of resources, and Sustainable meals. A systemic perspective and collaboration with entire value chains, as well as focusing on profitable business models for every actor involved, permeate our way of working.
Sustainable agriculture
We aim to convert agriculture to more sustainable cultivation methods and contribute to increased biodiversity and profitability for the farmer.

Sustainable seafood
The share of landed seafood that actually reaches consumers as food must increase significantly. Another possible pathway is to land and eat more of the underutilized fish species and types of seafood available. We explore value chains and product development to address this possibility.
Sustainable use of resources
Roughly a third of the world’s food is wasted. One effective way to make use of much more is to have residual streams from food production recirculated into the system. From pilot to large scale, we innovate and accelerate solutions for a more circular and resource-efficient food system, enabling more sustainable use of resources.
Sustainable meals
In a couple of decades, there are an estimated ten billion people on Earth. To be able to produce healthy food for everyone and stay within the planetary boundaries, the food systems need to be re-engineered. Today, an average Swedish meal generates 1.8 kg of CO2e, while a sustainable meal should result in 0.5 kg or less.
Nutrition, sustainability, and taste is our three-pillar focus when we develop ingredients, products and meals affordable for everyone to enjoy.
The practical work within the Future Food program takes place at Torsåker Farm together with producers, researchers, municipalities, industry associations, food processors, chefs, entrepreneurs and consumers. Through these collaborations, we make impact.

The Mineral Shift
Increased bioavailability in grain products
Our bodies absorb minerals from grains less efficiently than from meat. To support health and sustainability, the Mineral Shift project optimizes hydrothermal treatment to enhance grain mineral bioavailability, enabling absorption of iron and zinc almost as effectively as from meat.
Highlights
Pilot plant at Torsåker Farm: A pilot plant for Hidden in Grains to optimize parameters for hydrothermal treatment of grains was established at Torsåker Farm.
Test and development: The project has developed new products using hydrothermally treated barley, rye, and wheat.
Upscale to the market: Large-scale production and several testbeds at Torsåker Farm aim to make hydrothermally treated grain available on the market.


One of the most important changes for a sustainable food system is to reduce meat consumption and eat more plant-based foods, with an increased intake of whole grains and legumes. Today, nine out of ten people in Sweden consume less whole grains than recommended, while the consumption of red meat and processed meats is significantly higher than recommended.
Meat is an important source of iron, but the grains consumed by Swedes actually contain more iron than the amount found in

In the Mineral Shift project, a wide range of stakeholders has been collaborating since 2021 to solve the problem of low bioavailability. They aim is to develop the next generation of flavorful and healthy whole grain products using barley, rye, and wheat. At the core of the project is a traditional method known as hydrothermal treatment, refined and developed by the researchers behind the company Hidden in Grains. The method involves soaking the grains for a certain time and at a specific temperature. This activates the seed’s natural enzyme
“There is a need for products on the market that are both tasty and sustainable, and that allow us to absorb the minerals from the whole grain more efficiently.“
Veronica Öhrvik, Project Manager, Future Food
the meat, fish, and eggs they consume. The problem is that the minerals in grains such as wheat, rye, oats, and barley are bound to the antinutrient phytic acid, making them difficult for the body to absorb.
By increasing the bioavailability of iron and zinc in grains, there is great potential to enhance their nutritional value. This can lead to the creation of flavorful, sustainable, and nutritious food products that more effectively replace meat as a source of minerals.
processes – or tricks the seed into thinking it’s spring and time to release its stored minerals.
At Torsåker Farm, Hidden in Grains has established a pilot plant for the hydrothermal treatment of grains with the goal of scaling up and optimizing production. Within the project, Hidden in Grains and Warbro Kvarn are also planning a large-scale production facility. In this endeavor, Axfoundation shares experiences related to scaling up from previous successful innovations. To
Råggyberry, a healthy snack developed with partners at Torsåker Farm.
David Fredlund at Hidden in Grains in Torsåker Farm’s test kitchen.

grains
... ... and in the porridge at the 2024 Nobel Banquet.
enable hydrothermally treated grain to reach its full potential, advanced milling techniques have been used: vortex milling and micronization. In vortex milling, the full kernel is ground on a fixed grinding stone made using a constantly circulating air
Results
• The project has demonstrated that even with large-scale processing of whole grains, up to 99% of the antinutrient phytic acid can be degraded. This means that the grain kernel releases its minerals, making up to four times more iron and zinc available in the raw material for the body to absorb, than without the process.
• The project has developed new meals and products using hydrothermally treated barley, rye, and wheat. Hidden in Grains and Warbro kvarn has introduced new whole grain products to the market. Hydrothermally treated Swedish bulgur from barley is available for food service, and for consumers through Warbo Kvarn.
• Axfoundation, in collaboration with Dagab, Hemköp, Middagsfrid, Urban Deli, and Willys, developed Råggyberry, a snack for the future. The product was created according to Generation Pep’s criteria for a healthy snack.
• A range of products have been tested at Torsåker Farm: granola, porridge, pasta, pancakes, crispbread, cookies – and even sausages – with very good results.

current, while micronization is made using an advanced technique involving oscillating forces. These processes enable sifted wheat flour to be completely or partially replaced with whole grain in products like pasta, pancakes, cookies, and bread.
• MatLust Development Node/Södertälje Municipality has successfully tested Hidden in Grains’ products on schoolchildren in Södertälje. Among the products are bulgur, tabbouleh, and grains as ingredients in meat dishes.
• The vortex mill at Torsåker Farm has enabled testing of whole grain flour and has been used in collaboration with Region Stockholm within healthcare and elderly care. In the scaling-up phase, the vortex mill will be replaced by the significantly more efficient method of micronization.
• One goal of the project is to increase mineral intake among the elderly. As part of the project, pancakes made from processed whole-grain wheat have been tested in Tiohundra’s kitchen in Norrtälje that supplies meals to nursing homes.
• The 2024 Nobel menu was directly inspired by the Mineral Shift project, which, through the award-winning chef Jessie Sommarström’s culinary expertise and creativity, was transformed into hydrothermally treated whole-grain porridge.
Partners
The first phase of the Mineral Shift project was carried out 2021–2024 by the MatLust Development Node, operated by Södertälje Municipality, in collaboration with Axfoundation, Hidden in Grains, and Warbro Kvarn. Chalmers University of Technology’s Department of Food Science was also a partner. The initiative was funded by Vinnova.
Treated
in pancakes at nursing homes
Meet our partners
Kerstin Fredlund, Founder of Hidden in Grains, and David Fredlund, CEO.
The story behind Hidden in Grains is full of progress and setbacks. It started when Kerstin Fredlund made her own baby food for her first child, her son David, who was born in 1978. Nutritional deficiencies among children were common at the time, and in the traditional way, she soaked the grains to remove the phytic acid that binds minerals.
Kerstin realized she was onto something important and began learning more about how grains were traditionally prepared before eating. This forms the basis of hydrothermal treatment: soaking whole grains, drying, hulling, and grinding, which makes the minerals more accessible.
Soon, Kerstin impressed the emerging oat industry and gained the support of a baby
in Grains. The pilot operations were moved to Warbro Kvarn, and the Mineral Shift project began. Then, Warbro Kvarn burned down. Axfoundation offered Hidden in Grains a place at Torsåker Farm. There, they found the equipment they needed, their network expanded, and things started to gain momentum. David Fredlund explains:


– Moving to Torsåker Farm was actually the best thing that could have happened. It led to us collaborating with all the amazing people there, and we wouldn’t be where we are today without them.
“I knew the method was revolutionary.“
Kerstin Fredlund, Founder of Hidden in Grains
food company. She attracted attention but also faced resistance from skeptical pediatricians. As time passed, she became a mother of three, and her research continued alongside her work as a general practitioner.
Three food companies took out patents on the technique. However, nothing happened, and years went by. In 2015, the patent was released, and testing resumed with heritage grains at Saltå Kvarn. Kerstin’s colleague Anette Almgren conducted phytic acid analyses at Chalmers, but neither Kerstin nor Anette could see how to scale up the process.
Then, Kerstin met Axfoundation's Anna Henning Moberg, who immediately recognized the potential of the method. So did her son David, the one who had received the baby food in 1978. He left his career as an architect and became the CEO of the company, now named Hidden
Kerstin Fredlund agrees: – I had lost faith that we would ever succeed in creating a product. But the chefs at Torsåker Farm just got to work and made fantastic meals. I was so happy, I cried – it was all wins!
More ideas were born, and new opportunities emerged. Today, there are several products on the market, including barley bulgur and the snack Råggyberry, based on hydrothermally treated rye. The porridge served at the 2024 Nobel Banquet was made with hydrothermally treated whole grains. It showcased how traditional ingredients can be innovatively refined for the most elegant settings.
– I knew the method was revolutionary, but I couldn’t see how it would make its way to the table. Now we are so close to achieving health for people, says Kerstin Fredlund.

Fighting Antibiotic Resistance
Overuse in food production can be stopped
The majority of antibiotics are used in the animal sector, often for growth promotion in healthy animals. Healthy animals don’t need antibiotics. Since 2013, Axfoundation has worked with stakeholders to promote responsible antibiotic use in the food industry, both in Sweden and internationally.
Highlights
The Antibiotic Criteria: A hands-on toolbox for antibiotic responsible sourcing of food.
The Antibiotic Platform – from Farm to Fork: A wide range of actors across sectors meet to raise competence and share knowledge of work against Antimicrobial Resistance (AMR).
The Antibiotic Dialogue: Axfoundation regularly gathers food sector actors to drive the ambition with prudent antibiotic use in their supply chains.
Updates on Antibiotics: A free and open bi-weekly update on antibiotics, trade, and animal husbandry, curated by veterinarian Jenny Lundström, released by Axfoundation.

Increasing antibiotic resistance is one of the top ten global threats to human health, according to the World Health Organization (WHO) and the Public Health Agency of Sweden. The more antibiotics that are used, the greater the risk that bacteria will develop resistance, resilience, and immunity to the drug. The medicine simply does not work anymore.


However, in several other countries, the problem remains pervasive. Antibiotics are, in these instances, used not only when the animals are sick but for preventive purposes, and in routine group treatment to keep the animals healthy in a sub-standard environment. In many cases, antibiotics are also used purely for growth promotion
“Initiatives such as the Antibiotic project contribute to necessary whole-of-society solutions to the global threat of antimicrobial resistance.”
Dr Malin Grape, former Ambassador on Antimicrobial Resistance
Globally, at least 1.2 million people die each year due to diseases related to drug-resistant bacteria. From now until 2050, the number is estimated to increase dramatically to in total 39 million people, if actions are not taken to counteract the development.
Animals that are healthy do not need antibiotics. Yet, antibiotic overuse is a widespread problem, particularily in the food industry. There is a clear link between sub-standard animal husbandry and the extensive use of antibiotics.
Compared to many other countries, Sweden has a very low average consumption of antibiotics, demonstrating that it is possible to significantly reduce antibiotic use while still maintaining productivity.
purposes, a procedure that was banned in Sweden in 1986 and within the EU in 2006. In order to achieve responsible use of antibiotics that minimizes the risk of resistance development, increased responsibility is needed in all sectors that rely on antibiotics.
As the largest use of antibiotics occurs in animal husbandry, all actors in the food chain have a responsibility to minimize the development of antibiotic resistance.
Effective efforts that reach all levels require collaboration. Therefore, Axfoundation, together with companies, academia, authorities, industry associations, and civil society organizations, has in several initiatives worked to highlight the issue and encourage more actors to take action.
A schematic flow of how production, residues and use of antibiotics lead to resistent

Timeline – the Antibiotics project
2013 A xfoundation started collaborating with a broad network of actors to develop industry-wide antibiotic criteria for the Swedish food sector.
2014 The bi-weekly Updates on Antibiotics started.
2014 The Antibiotic Criteria 1.0 was launched.
2018 T he World Health Organization endorsed ReAct’s Toolbox on Antibiotics, in partnership with Axfoundation.
2019 The Swedish University of Agricultural Sciences launched their first free Massive Open Online Course on low use of antibiotics in livestock production, in partnership with Axfoundation.
2020 The Antibiotic Criteria 2.0 was launched.
2020 The Swedish Food Retailers Federation adopted an industry agreement based on the first six of the eight criteria.
2021 The Antibiotic Platform – from Farm to Fork was initiated.
2021 The Antibiotic Criteria 2.0 was awarded ‘Venture of the Year’ by the Sustainable Brand Index.
2021 The Antibiotic Dialogue’s first meeting.
2021/ Axfoundation took part of the expert 2022 group of the Swedish Government Official Reports regarding AMR and animal husbandry.
2022 A new set of procurement criteria for the European healthcare sector was released by Health Care Without Harm, inspired by the Antibiotic Criteria.
2022 A s tudy on consumer-driven demands for antibiotic-smart choices indicated that more information would impact purchase decisions. Contributors to the study were Axfoundation, Coop, and the Stockholm School of Economics.
2023 A xfoundation became member of the AMR Multi-stakeholder Partnership Platform, coordinated by WHO, WAOH, UNEP and FAO.
2024 Global Leaders Group om AMR visited Torsåker Farm during their meeting in Sigtuna, Sweden.
Antibiotic Project Results
• 100% of the Swedish food retailers use the Antibiotic Criteria, as do the largest food wholesalers and several food producers.
• The National Agency for Public Procurement’s criteria are aligned with the Antibiotic Criteria.
• The Antibiotic Criteria have inspired Health Care Without Harm, a European network of thousands of hospitals and other healthcare facilities, to develop their own set of criteria targeting food procurement.

Axfoundation’s Maria Smith at The Royal Swedish Academy of Agriculture and Forestry.
Partners
• 4,200 people from more than 100 countries have finalized the Massive Open Online Course on effective livestock production with low use of antibiotics. The MOOC was developed by SLU in 2019, in partnership with Axfoundation.
• While not a direct result of the project, it’s worth noting that The Swedish National Pension Funds’ Council on Ethics has selected AMR as one of five focus areas for its corporate engagement efforts.
Our Recommendations
To policy makers and authorities:
• Make sure Sweden takes the lead and showcases that prudent use of antibiotics in animal husbandry is doable.
• Be a frontrunner and influencer in global dialogues and concerning EU regulations.
• Ensure that national antibiotics use data is collected in a systematic and detailed way.
To retailers, food service, and food producers:
• Make a public commitment with clear goals when it comes to products and supply chains.
• Collaborate and increase knowledge by joining seminars arranged by the Antibiotic Platform – from farm to fork.
• Be transparent and engage suppliers and consumers.
The Antibiotic Criteria 2.0 was developed by Axfoundation in collaboration with a group of experts from the Beijer Institute/Stockholm Resilience Center, Friska Djur (Healthy Animals), and the Swedish University of Agricultural Sciences, SLU.
In addition, a broad reference group actively participated in the development, with representatives from the food industry, civil society, academia and government; Axfood, Coop, Findus, Gård & Djurhälsan, ICA, Lidl, The Swedish Food Federation, The Federation of Swedish Farmers (LRF), Martin & Servera, SIWI, The National Veterinary Institute, (SVA), Swedish Food Retailers Federation, The National Agency for Public Procurement, Vi Konsumenter), World Animal Protection, and WWF Sweden. The Antibiotic Platform is jointly operated by Axfoundation and KSLA.
Updates on Antibiotics is a collaboration between Axfoundation and antibiotics expert Jenny Lundström. Click here to subscribe for a biweekly news update.

SensAlg
Making algae a part of everyday meals
Blue food has great potential to contribute to a sustainable food system. Algae are full of nutrients and deserve more recognition than just being consumed with sushi.
There are many benefits to algae. Its cultivation doesn’t compete for farmland, no fertilizers or pesticides are used, and nutrientloaded waters are purified in the process. Also, the yield is substantial – nearly 20 tons of algae are produced per hectare each year.
Eating algae is not only environmentally beneficial; algae are also a good source of minerals, Omega 3, fiber, and protein. Despite all these advantages, the availability remains modest.

The SensAlg project will develop an entirely new sensory knowledge base for how algae should be cultivated, processed, and included in food to maximize acceptance and consumption. Studies will be conducted together with children and adolescents in Sweden and across Europe.
In collaboration with algae farmers, food producers and researchers in algae cultivation and sensory science, we aim to make algae a part of everyday meals.
Axfoundation believes in more uses for algae than just as a dried product. At Torsåker Farm, products and concepts containing around 20% frozen algae will be developed. Axfoundation will also explore the market’s needs and demand.
Partners
Uppsala University, Chalmers University of Technology, University of Gothenburg, Nordic Seafarm, Fisk Idag, Veg me, Georg-AugustUniversität Göttingen, Ghent University, and University of Milan. Funded by Formas.
Fried seaweed with flaky salt.

Feed of the Future
Feed for fish, pigs, poultry, and laying hens
Feed accounts for 75–90% of CO2 emissions in fish and poultry production, often using ingredients humans could eat. The Feed of the Future project tests low-impact feed to replace imported soy. The goal is to establish production of pork, fish, chicken, and eggs from animals fed circular feed.
The food system accounts for about 1/3 of the global greenhouse gas emissions and is the biggest cause of loss of biodiversity. In turn, the production of food from animals has the greatest impact in the sector, and the feed is responsible for 50–85% of climate emissions from poultry, eggs, fish, and pigs.
Highlights
Only about 16% of the Earth’s habitable land is suitable for farming. A significant portion of croplands is used to produce animal feed, making feed one of the most critical challenges. At the same time, food waste is a major problem – 1/3 of everything that we produce never reaches a human stomach.
Built on learnings: The project builds on the ‘5 Tons of Green Fish on the Plate’ project, which proved rainbow trout can be farmed using feed from insects that ate food waste.
New feed ingredients: Insects, mycoprotein, and mussels are being tested and evaluated in this project as feed ingredients for pigs, poultry, and laying hens.
Business modeling: Assessment of the market potential of the final animal products.
Blue mussels from the Baltic Sea can replace components in conventional feed.

“It’s almost too good to be true – a fish that tastes good and contributes to healthier oceans. But we’ve shown that it’s possible, and we’re going to scale it up.“
Christian Sjöland, Project Manager, Future Food
The ‘Feed of the Future’ project addresses these two food system problems by aiming to replace land use with food waste. The Axfoundation pilot ‘5 Tons of Green Fish on the Plate’ demonstrated that rainbow trout can successfully be fed insect-based feed, which has a 30–70% lower climate impact than conventional feed.
Building on these insights, the Feed of the Future project aims to scale the transition from conventional to circular fish feed on a large scale and at the national level. The project brings together stakeholders from across the entire food chain. Another aim of the project is to test and evaluate innovative feed ingredients for pigs, poultry, and laying hens.
Running from 2023 to 2025, the first phase focused on testing the nutrients and

digestibility of the new feed ingredients. Gastronomic and sensory evaluations of the eggs and meat products will take place at the end of the project.
The overarching goal is to enable Swedish production and sales of poultry, eggs, pork, and fish raised on low-environmentalimpact feed. This feed uses resource-efficient ingredients that support biodiversity and has the potential to replace a significant portion of today’s conventional feed. Particularly interesting ingredients include the Black soldier fly larvae, fed on residual flows from the food industry, and mycoprotein grown on forest industry by-products.
Another example is blue mussels from the Baltic Sea. These protein-based feed ingredients are expected to replace several components in conventional feed, such as

Black soldier fly larvae, fed on residual flows from the food industry.
soy and wild-caught fish, both of which have major negative effects on the climate and biodiversity. The meat and eggs from the pilot tests will undergo sensory evaluation by researchers at Campus Grythyttan, and additional assessments from a gastronomic perspective will also be conducted. The aim is to sell the products to both restaurants and grocery stores.
Axfoundation leads the project and is responsible for the sensory and gastronomic testing of the finished products. This will be followed by a joint effort alongside actors within the food industry and food service, to then contextualize how these products can best reach the market.
Results
• Svenska Foder has had its facility approved for handling insect meal.
• Ragn-Sells has built Sweden’s first value chain approved for producing insect meal for feed.
• Comprehensive nutritional analyses have been conducted on mussel meal from the Baltic Sea and defatted insect meal (BSF) from Ragn-Sells.
• Nutritional analyses show that the products contain high protein levels and valuable micronutrients.
• Digestibility studies have been conducted on fish fed with feed containing mussel and mycoprotein.
• VARVA, a company producing eggs and soil nutrients, has started container-based insect farming. The insects are fed vegetable waste streams from a local grocery store, and the larvae are used to feed their laying hens.

Our Recommendations
To policy makers and authorities:
• Subsidize new sustainable raw materials. As a comparison, the biogas industry is heavily subsidized, even though insects offer nearly twice the climate-saving benefits if food waste is directed to them instead of biogas.
• Provide the same level of information about the production animal ‘insects’ as about the production animal ‘cattle’.
• Investigate and specify which substrates are approved for insects and mycoprotein.
• Synchronize legislation, permits, and information across authorities.
• Introduce compensation for waste management for insects and mycoprotein, and for water purification for mussels.
To retailers:
• Letters of Intent are not sufficient; many producers are entirely dependent on a purchase agreement from retailers committing to buy a certain amount of animal products continuously. Without this, feed companies are not interested.
Partners
Axfoundation is the project manager, and SLU is the coordinator. Partners include Axfood, Boden Municipality, NovaPro, Ekobolaget, Ecoloop, Ecopelag, Fiskhallen Sorunda, Grönsakshallen Sorunda, Johannas Stadsodlingar, Kötthallen Sorunda, Lantmännen, Martin & Servera, Plant Protein Production, Ragn-Sells, School of Hospitality, Culinary Arts and Meal Science Örebro University on Campus Grythyttan, RISE Processum, Stjärnägg, VARVA, Svenska Foder, Viking Fågel, and Älvdalslax. The project is partially financed by Sweden’s Innovation Agency Vinnova.
At Ragn-Sells’ facility in Orsa, the Black soldier fly is bred and fed with vegetable waste from the food industry.

Laying Hen
Aiming for the revival of a wasted resource
We consume more eggs but little hen meat, wasting a valuable resource. Axfoundation collaborates with Stjärnägg to create tasty dishes from spent laying hens, promoting better use of egg-producing birds.
It used to be easy to buy and cook hen. Nowadays, it’s hard to find in the store and only a small amount of the slaughtered hens is consumed in Sweden. The market has long been flooded with extremely cheap chicken.
Sweden has nearly 9 million laying hens, with 5.5 million replaced yearly after 80–90 weeks of egg production. These hens are often treated as waste, incurring disposal costs. Utilizing meat from egg-laying hens offers significant potential, ensuring industry responsibility for the entire value chain. The ambition is to find innovative solutions for meat from Swedish laying hens.
In the test kitchens at Torsåker Farm, Axfoundation explore delicious, nutritious,
and sustainable products made from hens. Axfoundation acts as the link between the packing facility, slaughterhouse, and retail, actively involved in the work with Stjärnägg’s sustainable slaughter project. One challenge is that there is only one large-scale slaughterhouse for laying hens.
Partners: Stjärnägg and Dagab/Axfood.
Results
• Axfoundation has developed product examples to help the laying hen sector find direction in product development.
• A project led by Stjärnägg focused on animal welfare and sustainable slaughter.

TRANSECO
Aligning profitable and sustainable farming
The global food system depletes soil and outpaces pest control efforts. Agroecological farming balances productivity and ecosystem health. TRANSECO compares 30 Swedish farms using different levels of agroecological principles, assessing economics, ecology, soil fertility, and scaling potential.
The global food system stands as one of the major causes of biodiversity loss. The rationalization within agriculture has led to larger fields and more intensive cultivation systems with higher use of mineral fertilizers and pesticides, and increased greenhouse gas emissions. Other effects are a reduction in soil biodiversity, and nutrients leaking into waterways, causing eutrophication and acidification, resulting in disrupted ecosystems.
What we are also seeing is a reduction in the effectiveness of pesticides and fertilizers as crops mutate faster than new pesticides are developed. And when soil microorganisms disappear, more fertilization is needed. Another factor negatively affecting
biodiversity is the compaction of soil by heavy machinery, making it harder for insects, worms, and microorganisms to thrive and perform their ecological functions.
The solution lies in a food system where farmers find “the perfect middle ground”, with reduced mechanical and chemical processing, allowing increased microbial life to restore soil fertility.
The project investigates agroecological grain farming, where farmers reduce the use of chemical pesticides and fertilizers, replacing them with enhanced ecosystem services. The economics and ecology of 15 farms using agroecological principles are being compared with 15 conventional farms in Sweden. This

comparison will contribute to understanding how agroecological methods can affect farm yield, ecosystem services, and agricultural economics in a changing climate.
Axfoundation’s role in TRANSECO is to ensure the project’s commercial viability, enabling research results to support farming that is both sustainable and profitable. Stakeholders across the entire food chain, from farm to table, participate in the project to evaluate and develop efficient cultivation methods and market solutions that facilitate the transition to sustainable agriculture.
TRANSECO assesses to what extent a farm practices agroecology. Instead of classifying a farm as either organic or conventional, the assessment is based on five parameters:
1. The quality of crop rotation
2. The amount of pesticides used
3. The quantity of fertilizers used
4. S oil tillage practices
5. Use of cover crops
Meet our partner
Riccardo Bommarco, Professor in Ecology, Swedish University of Agricultural Sciences.
What opportunities do you see with the TRANSECO project?
– We researchers have primarily collaborated with farmers and other practitioners in agriculture, so it’s very exciting and inspiring to engage with actors across the entire food value chain. Key outcomes we are exploring include the ecological and economic efficiencies, as well as tradeoffs that arise when implementing more sustainable farming practices. The business and marketing solutions developed in TRANSECO present a major opportunity.

What are the challenges?
– Transitioning an agri-food system is no easy task. Moving towards an agroecologically-based food system as the mainstream solution requires supportive policies from society. A core aim of the project is to identify such levers for change.
How far are we from transitioning towards more agroecological farming in Sweden?
– We are still quite far from this transition. Since the 1990s, the structural changes in Swedish agriculture have led to a lower diversity of crops per farm and a geographic separation of animal and crop production. On a positive note, farmers and advisors are increasingly interested in implementing agroecological farming practices and many farmers already do.
Partners
The TRANSECO project is led by the Swedish University of Agricultural Sciences (SLU), responsible for interdisciplinary research in both ecology and economics, together with Axfoundation, Abdon Food, Axfood, and 30 farmers in Skåne.

Sustainable Agricultural Practices
For better soil health and carbon sequestration
Soil degradation is a critical ecological challenge. Increasing soil carbon lowers CO₂ levels and improves soil health, boosting resilience to droughts and floods. Axfoundation promotes sustainable farming practices, including regenerative farming, conservation agriculture, and agroecology.
Topsoil forms the foundation of our food production, yet it is currently being depleted, contaminated, and eroded in many parts of the world. This leads to a long-term decline in production capacity and reduced yields on
Highlights
lower-quality soils. Additionally, agriculture is a significant source of greenhouse gas emissions. According to estimates from the Intergovernmental Panel on Climate Change (IPCC), 20–30% of global greenhouse
Research hub: Torsåker Farm provides land to researchers and projects testing analysis methods and soil monitoring sensors to study soil health and biodiversity under various cultivation conditions.
Test plots and sampling: Among other things, four test plots are monitored through annual soil sampling, and environmental DNA is sampled from insects and soil.
Soil sampling is being conducted annually at Torsåker Farm to test soil health.

“There’s no single solution that will solve these issues. Instead, it’s the combination of different farming methods that together contribute to reducing environmental impact.”
Maria Lundesjö, Project Manager, Future Food
gas emissions originate from forestry and agriculture. To address the climate and environmental issues associated with current agricultural systems, an increasing number of researchers emphasize the need to adopt sustainable cultivation methods. To determine which methods actually yield the desired results, various techniques need to be tested in practice, evaluated, and adapted to the local conditions on each individual farm.
At Torsåker Farm, Axfoundation convenes researchers and farmers to examine techniques and cultivation methods that promote improved soil health and carbon sequestration in agricultural land. In collaboration with the carbon sequestration platform Svensk Kolinlagring, Axfoundation has established an intensive sampling site at Torsåker Farm. The aim is to gather knowledge on how different cultivation methods and crops affect soil health. Data from various measurements are collected and shared with different research projects. The data from the sampling is supplemented by a sensor station that records weather, wind, and soil moisture.
Axfoundation’s ambition is to increase the level of knowledge among Swedish farmers, advisors, and agricultural machinery manufacturers, as well as assisting Swedish farmers in transitioning to sustainable methods without risking crop and profitability losses.
Partners
In the long run, the ambition is to increase the organic matter content and carbon sequestration in Sweden’s arable land.
Torsåker is also one of the test farms in the Mistra-funded program FinBio. Part of the program is about finding a useful method for measuring and monitoring the impact of different agricultural methods on biodiversity. Environmental DNA methods (eDNA) are tested using Malaise traps (tents that catch insects for a limited time) and soil samples from fields that use management practices for increased carbon sequestration. Hopefully, the tests can facilitate the work of developing business models that enable investments in actions that lead to increased biological diversity.

Svensk Kolinlagring – a collaboration aiming to increase carbon sequestration in Swedish agricultural soils. Axfoundation is also actively involved in several working groups and reference groups for various research projects in the field, including Soils for Europe (SOLO), a project within the EU Horizon program. We act as a test farm for researchers within the programs AgTech Sweden, Mistra FinBio, and the Swedish University of Agricultural Sciences (SLU).
Malaise traps are catching insects in the fields at Torsåker Farm.

Blood & Turnip
Tasty, healthy and sustainable food from waste
Only 3% of cattle blood at Swedish slaughterhouses is used; the rest becomes biogas. Many resources in Swedish food production are underutilized. The Blood & Turnip project aims to turn these into tasty, healthy, and sustainable food products.
A substantial proportion of the food produced is lost in the steps from being produced to ending up on plates. Irregularly shaped vegetables and meat by-products are only a few examples of underutilized resources in Swedish primary production and food industry. For instance, half of the meat by-products from beef and pork that could be used as food end up being converted into biogas or used as animal feed.
The blood from cattle and pigs at Swedish slaughterhouses – which could be used as food – instead goes to biogas. The reason is that it’s technically difficult and expensive to process. Hence, the profitability is often
low of these types of raw materials. To achieve the Swedish interim target “An increased share of food production should reach stores and consumers by 2025”, all actors in the Swedish food chain need to move from passive to active.
In the Blood & Turnip project, Axfoundation works together with partners to assess the potential of raw materials that have previously become waste, biogas, or feed by upgrading them into tasty, healthy, and sustainable food products. The aim is to contribute to increased resource efficiency and profitability in the Swedish grocery sector. The project, led by IVL Swedish Environmental Research Institute,
Black brownies – bloody good sweat treats.
investigates chemical and microbiological risks, profitability, and environmental impact of various underutilized resources in vegetable farming and meat production.
Axfoundation conducts environmental and nutritional impact assessments with economic evaluations. At Torsåker Farm, new foods are being developed from raw materials or resources that are safe and environmentally sustainable. The work is being done in close collaboration with sensory experts at Ipsos to develop products that suit both younger and older people. The ambition is to contribute to tasty and healthy food served in the public sector, for example in schools or nursing homes.
Results
• The potential for upgrading food losses was evaluated in terms of environmental and nutritional impacts, combined with an estimated market potential.
• A range of new products made from the sidestreams have been developed and tested: blood, kidney, press residues from apples and carrots. Taste buddies for the different raw materials were identified. For example, for blood – chocolate was identified as a taste buddy that intensified the chocolate taste. Another advantage of using beef blood is that it can replace eggs, as blood has the same coagulating effect when heated.
• Of the developed products, five were selected for sensory testing with young people and the elderly. The tests, conducted by Ipsos, led to one product being chosen for production. Two other products showed great potential and will undergo further development.
• The products with the highest ratings were evaluated based on nutritional quality, environmental performance. Suitable producers were identified.
Partners
Meet our partner
Emma Moberg, Researcher at IVL (Svenska Miljöinstitutet) within sustainable food consumption and food waste.
How good or bad are we in Sweden at utilizing residual streams in the food industry?

– The Western world is characterized by industrial food production and a modern food culture where slaughter byproducts go to biogas or animal feed, and crooked carrots are sorted out on the assembly line. There is a lack of demand and profitability for residual streams.
What is needed to change this?
– There needs to be a shift in norms, and it can start as early as in schools. But new infrastructure is also required, such as new machines to make use of pressing residues in different ways. In the end, the products must be attractive and profitable. Government support may also be needed to utilize residual streams.
How does the Blood & Turnip project contribute?
– We aim to produce two product prototypes that can serve as learning examples for others in the industry and researchers. What has emerged so far at Torsåker Farm is much more impressive than we expected – it’s innovative and exciting.
The project is run by IVL Swedish Environmental Research Institute and is carried out in collaboration with Axfoundation, the association Matsvinnet, Ipsos, and the Swedish University of Agricultural Sciences (SLU), Department of Energy and Technology. The project is funded by Formas and goes on until the end of autumn 2025.

Axfoundation’s Maria Lundesjö and Marit Wirén Toll test the moisture content in the seeds.
Perennial Cereal Grains
The revolution continues
At Torsåker Farm, Axfoundation and the Swedish University of Agricultural Sciences are testing Kernza® (perennial wheatgrass) and bulbous barley, the first perennial barley. These innovative crops offer potential environmental and economic benefits through groundbreaking long-term field trials.
Highlights
Perennial crops: The fields at Torsåker Farm host one of the world’s most diverse collection of intermediate wheatgrass plants – a perennial relative of wheat. Also, wild bulbous barley is cultivated for domestication and breeding of the world’s first perennial barley crop.
Ongoing research: The large diversity of the two perennial species are studied for desirable growth and harvest traits, and the best plants are selected for further domestication.
Potential: In collaboration with chefs and bakers, the commercial potential is investigated.

Perennial crops, with the ability to grow year after year without replanting or annual plowing, could make a valuable addition to sustainable agriculture. Among the core benefits is their ability to utilize the full, long growing season for carbon uptake through photosynthesis and growth. Additionally, carbon storage in roots and soil may lead to a reduction in greenhouse gas emissions and help mitigate climate change.
Today’s annual cereal crops, like barley and wheat, have been improved through breeding for hundreds of years with such a strong focus on high yields that they have lost properties that are now important for adapting to climate change. All cereals grown today in temperate climates are annuals and start from scratch every growing season: The land must be plowed, the seeds sown, the crop established, and then harvested – never to return unless the procedure is repeated and the farmer sows again.
Axfoundation supports the efforts to develop perennial grain crops with the potential to revolutionize agriculture. Torsåker Farm has been established as a long-term field site for perennial cereal grains, such as intermediate wheatgrass and bulbous barley. Axfoundation’s contribution is also to work with chefs and bakers to identify the commercial potential of the perennial grain crops and explore which foods the cereals would be best suited for.

Pizzas baked with flour from Kernza.

Intermediate wheatgrass (Kernza®)
Kernza® has been developed through the domestication and breeding of a perennial relative of wheat, intermediate wheatgrass (Thinopyrum intermedium). The initial work was conducted by plant breeders at the Rodale Institute in Pennsylvania, USA. Since 2003, the breeding of intermediate wheatgrass has been led by The Land Institute in Salina, Kansas.
By selecting the best plants based on traits such as seed count, seed size, and other harvest characteristics, improved populations have been developed. To further enhance and adapt cultivars for farmers’ conditions in Sweden and other regions of northern Europe, breeding efforts are being carried out at Torsåker Farm.
Results

Bulbous barley
Can bulbous barley, originating from Central Asia, thrive in northern and central European climates? An extensive domestication and breeding program for the wild relative of barley, Hordeum bulbosum, is underway at Torsåker Farm to develop the world’s first perennial barley crop – bulbous barley.
Torsåker Farm is the first, and to our knowledge currently the only, location in the world dedicated to the domestication and breeding of bulbous barley. Genetically unique plants from diverse geographical regions and climates are grown in field trials and evaluated for various traits to select the best plants. The goal is to improve agronomic traits such as harvestability and yield, while adapting the plants to thrive in northern and mid-European climates.
• A large diversity of intermediate wheatgrass plants has been evaluated, and the best plants have been selected and crossed over several plant generations to improve the crop.
• The plant domestication and breeding program focuses on desirable traits such as high seed yield, uniform ripening, resistance to shattering, and other harvest and yield traits.
• To make the selection of the best plants even more precise and efficient a breeding method, genomic selection, is under development.
• Half a hectare of land has repeatedly been harvested, showing it is possible to thresh the intermediate wheatgrass with a standard combine harvester.
• For bulbous barley, a large diversity of plants from different geographical origins have been evaluated and selected for seed and harvest traits.
• Axfoundation collaborates with chefs and bakers to identify the commercial potential for these perennial grain crops. Pizzas and bread baked with Kernza flour are some of the results.
Partners
The domestication and breeding programs are run by the Swedish University of Agricultural Sciences (SLU) in Uppsala, and the researcher in charge is Associate Professor Anna Westerbergh. The research on genomic selection for intermediate wheatgrass is carried out in collaboration with The Land Institute and is partially financed by Wasabröd. The domestication and plant breeding on bulbous barley is carried out in collaboration with the University of Copenhagen and Carlberg Research Laboratory, Copenhagen.


Swedish Herring
From animal feed to daily meals
Only a fifth of Sweden’s fish catch reaches the plate – a waste the Swedish Herring Mince project aims to change by repurposing herring meat once used for fish feed into flavorful mince.
Less than 20% of Sweden’s fish catch becomes food. Around 75% goes to feed. To make use of a fantastic ingredient that currently becomes fishmeal, both an innovative process and market demand are essential.
A crucial component is the process developed by Sweden Pelagics and Chalmers University of Technology for handling herring and similar fish. This process adapts the classic fillet line in the fish factory, allowing more parts of the fish to be separated. As a result, the delicate fish meat becomes easier to handle and can be used in products like mince, which can then be incorporated into a range of foods.
To prevent rancidity and bacterial growth, the fish mince is dipped in an antioxidant bath with extracts of rosemary, citric acid, as well as vitamins E and C. This results in a welltasting herring mince made from byproducts,
Partners
with high quality and long shelf life. Axfoundation’s role in the project is to test the mince in Torsåker Farm’s test kitchens to develop new, attractive, and healthy products for consumers. We aim to increase market demand and interest in herring mince made from byproducts, and to broaden its range of uses.
By collaborating with, among others, the meal kit company Middagsfrid for product development and consumer information, solutions can be tested before scaling up to restaurants and public kitchens.
Result
In early 2024, the ‘Sillenbergare’, a blend of herring mince and legumes, was the first product from the project reaching the market in selected stores and restaurants.
Sweden Pelagics AB, Middagsfrid, Urban Deli, and Chalmers Department of Life Sciences.
Nutritious crispy bream croquettes based on Swedishcaught fish.

Smart Swedish Seafood
The entire catch on the plate
Despite Sweden’s vast coastline and lakes, 75% of consumed fish is imported. The Smart Swedish Seafood project unites stakeholders to increase the use of more species and whole fish, aiming to strengthen sustainable fishing in inland waters and the Baltic Sea.
In Sweden, the main seafood consumed are salmon, shrimp, herring, and cod – these four species together account for almost 65% of all blue food consumption.
Additionally, Sweden imports three-quarters of all fish consumed while less than 75% of the fish caught is used for food. Instead, a large portion of fish is used for feed. In the Smart Swedish Seafood project,
Highlights
stakeholders from across the value chain collaborate to strengthen long-term and sustainable inland and Baltic Sea fishing.
The project is a follow-up and scaling of the previous project ‘Underutilized Fish Species’, which resulted in large-scale infrastructure for the handling, processing, and sale of Swedish freshwater fish, as well as products for food service and consumers.
Inland and Baltic Sea fishing: Stakeholders from across the value chain collaborate to strengthen long-term and sustainable inland- and Baltic Sea fishing.
Market evaluation: The project explores the market’s needs and demands, intending to develop profitable products and concepts.

“There’s a high demand from restaurants for boquerones made from male vendace, which previously went to animal feed. We’ve increased production from 350 kg to 40 tons of fish for this purpose in just one year.”
Mattias Dernelid, Smakriket, Grönsakshallen Sorunda
The Smart Swedish Seafood project maps and evaluates fish that currently become bycatch, biogas, or feed. One of the results is using male vendace for human consumption instead of animal feed. Thanks to its roe, vendace has an inherent appeal that suits restaurants well.
A high-value product that can be made from male vendace is boquerones. This year, 1,600 tons are being fished, half of which are
Results
• Within the project, a product of vendance was launched in 2023 at restaurants in Stockholm: boquerones. The demand was far above the accessibility and in 2024 the production increased 10 times.
• So far, additionally two products have been developed during the project and collaborations with interested food producers have been initiated.
• Collaborations between fisheries have been developed, resulting in more efficient use of existing equipment.
• New climate data for bream, burbout (freshwater cod) and vendace has been calculated by Sweden’s research institute RISE. The climate footprint of Swedish bream and burbout is less than a third of that of imported salmon and the footprint of vendance is even lower.
male vendace. What once held low value has suddenly gained high value. The task moving forward is to unify efforts and drive progress.
Additionally, we are assessing market needs and demands with the goal of developing profitable products and concepts. This may involve adapting existing infrastructure or exploring new development opportunities, while analyzing nutrient content and environmental pollutants.

Our Recommendation
Innovations must start small, but if scaling is hindered by the lack of sustainability certifications, they will never reach their full potential or access larger markets. For small-scale fisheries, obtaining certification is an expensive and time-consuming process. Developing a tailored certification process for smallscale fisheries could accelerate growth and increase the diversity of consumed species.
Partners
Guldhaven, Sveriges Fiskares Producentorganisation, Swedish Fish Auctions, Swedish Inland Fishermen’s Federation, RISE, Race for the Baltic, Martin & Servera, and Kalmar-Öland Trädgårdsprodukter. Parts of the Smart Swedish Seafood project are financed by the Swedish Board of Agriculture through the project ‘Blue Value Chains for Vendace, Bream, and burbout’.

More Legumes on the Plate
Making the potential of beans tasty
Legumes should play a significant role in the Nordic dietary pattern, according to the scientific advice of the Nordic recommendations. To increase the consumption of Swedish-grown and Swedish-processed legumes, Axfoundation collaborates with a wide range of stakeholders to develop the value chain for legumes and create tasty products and recipes.
Replacing meat with other protein sources, such as legumes, benefits both health and the environment. For several years, Axfoundation has been trial-cultivating new and older varieties of legumes and developing various products that are now sold in stores and through wholesalers.
However, there is still a vast untapped potential in beans, lentils, and peas as
raw materials in food – with innovative applications ranging from legume-based mince to legume flour. A key success factor in boosting legume consumption among consumers is to create products that can be easily incorporated into everyday cooking. Legume flour can play an important role in this, which is why Axfoundation is involved in the Legume Flour project, led by KalmarÖland Garden Products.
Results
• A value chain for Swedish-grown and processed legumes has been established, enabling large-scale production of Swedish legumes.
• The potential of legumes in product development has been successfully demonstrated, creating increased demand for legumes produced in Sweden.
• Swedish legumes are now used as ingredients in various products. A good example is Fish cakes with bream and fava beans, developed within the earlier Underutilized Fish Species project.
Meet our partner
• Swedish Legume Mince is currently sold wholesale (under the brand Svensk Baljväxtfärs) and in grocery stores (under the brand Svenskodlad Vegofärs).
• The Swedish Legume Mince has made its way into home kitchens, school kitchens, and lunchrooms. It’s also included in chef Jessie Sommarström’s 50/50 Meat and Bean Patty, which is sold at IKEA.
• The main course at the 2024 Nobel Banquet was a quenelle made from chicken and legumes, a 50/50 dish made of half meat and half legumes.
Håkan Johnsson, CEO of Kalmar-Ölands Trädgårdsprodukter, a farmerowned association which handles 4,000 tons of legumes per year.
With a long background in the food industry, Håkan Johnsson has never felt as motivated as he does now. Legumes are both climate-smart and rich in protein and fiber; there is enormous potential. Still, many people don’t even know what legumes are, says Håkan.
At Kalmar-Ölands Trädgårdsprodukter, brown beans, white kidney beans, and black kidney beans are the most prominent, but the Swedish climate is suitable for many types of beans and peas. Håkan believes that to get consumers interested in Swedish legumes, it is crucial to increase the degree of processing in Sweden and develop new products that people will want.

– Here, Axfoundation is an exciting player that has been very driving throughout the entire journey. I’ve been out spreading the word a lot, and many are interested, but it takes time. Now we are leading the way together, and things are starting to happen.
Håkan’s vision is to grow and become a hub in the Nordic region for legumes – not just for cultivation but also for processing. He claims that legume flour has immense potential, particularly as an ingredient in meat and poultry products. Swedish-produced goods have gained status and Håkan wants to ride this wave.
– But ultimately, the food industry, retail, and consumers must be willing to pay the growers. The strength of the ‘More Legumes on the Plate’ project is that everyone in the chain is involved, and academia is working hand in hand. Things are starting to happen.
Partners
Kalmar Ölands Trädgårdsprodukter, Sevan, SLU, Axfood, and Martin&Servera. In the “Legume Flour” project, partners also include Linneuniversity/Faculty of Health and Life Sciences, Lund University, RISE, CLUK, Ljungkvist Industriservice AB, Ulla Nilsson Konsult AB (project leader), Orkla Foods, Lantmännen, and Treans Lantbruk.

Future Materials

Axfoundation’s Program area that develops solutions for circular and resource-efficient material systems .

From More to Better
The ever-increasing and unsustainable consumption of resources and materials is the primary driver behind climate change and many other environmental issues. Although the circular economy has become a megatrend, too little is done due to the complexity of the transition. Now is the time to act.
Rapid economic growth and improved welfare globally have increased the demand for materials. Over the past 50 years, material consumption has tripled and without swift, concrete solutions for the sustainable use of natural resources, material consumption could increase by another 60% by 2060. Most business models do not consider products’ onward path after they are used. There is no waste in nature, but as for humans, waste is built into the very heart of our economy.
What will it take to transform our throwaway economy? The transition from a linear to a circular economy suggests
carbon emissions could be halved and people's needs be met, using only onethird of the materials currently consumed. Unfortunately, circularity in society is decreasing, and 95% of all material value is lost after one lifecycle.
This leads to significant value losses since materials are burned, landfilled, or downcycled, leading to a decrease in quality. In Sweden alone, at least 42 billion SEK in business opportunities are lost every year because of this.
A systems approach and collaboration are essential for turning theories, research,
“I hope for a mindset shift where we value and make full use of everything we produce, while also recognizing the importance of keeping materials and products in circulation.”
Hanna Hobohm Skoog, Programme Director, Future Materials
and good ideas into commercially viable solutions for circular and resource-efficient material systems. This is what we aim to contribute to within the Future Materials program area. Our efforts are divided into two focus areas: The Material Shift and Circular Transition.
1. The Material Shift
Material consumption primarily relies on finite, fossil-based raw materials and unsustainable global value chains. Despite the resource intense processes of making materials and products, leading to severe environmental and climate impacts, substantial residual streams occur as a result of inefficient and streamlined production. We do not value our finite resources enough and wasting is way too easy. To reduce the impact of our materials, we need to make full use of all resources, including residuals and waste, to their highest value and transition to biobased materials.
A focus on local and underutilized biomaterials strengthens resilience and minimizes supply chain vulnerability while also enabling companies to build transparent and sustainable value chains. There is time for a radial material shift – where we make use of everything produced in a regenerative and renewable way.
2. Circular Transition
The material shift will not alone solve the crisis we are in. To truly lower the impact of our material consumption, we have to consume less. It is crucial we decrease the total resource use in absolute terms by slowing down the throughput

of materials and make sure the ones we put in the economy are put in circular systems. At the same time, companies must create profitable business. We need scalable solutions that decouple business development from increasing resource consumption.
This requires a shift towards circular strategies and business models that keep materials and products circulated for as long as possible by being maintained, shared, reused, repaired, refurbished, remanufactured, and, as a last resort, recycled.
The systemic flaws built into the modern throwaway economy may seem difficult to solve. In theory, the solutions are there, but in practice, this requires major system shifts, and these are what we focus on.
From finite to renewable: Raw materials should come from biobased sources that regenerate nature.
From waste to resources: Waste should be treated as a design flaw, and residuals’ intrinsic value should be considered a business opportunity.
From linear to circular: Materials should be kept in circulation at their highest value through circular systems and business models.
Torsåker Farm is where systemic theories are transformed into practical solutions. Here, we can test, evaluate, and scale solutions for material innovations. Our aim is to develop a test center, bringing together our extensive network of partners to learn, innovate, and accelerate sustainable solutions that benefit society, businesses, and the planet.

With a simple scan, detailed information about the product’s raw materials, production process, and sustainability data can be accessed.
The Fiber Traceability Initiative
Toward transparent value chains and circularity
“Out of sight, out of mind” reflects how ignorance stems from the unseen, like production journeys of most products. The Fiber Traceability Initiative beta tackles this by mobilizing brands and suppliers across sectors to achieve transparent value chains.
Highlights
Common business language: GS1 standards are implemented in sheep farms, scouring facilities, spinning and dyeing mills, and manufacturing units, and in the fashion house Filippa K. QR code in the garment: The next generation of QR codes is sewn into garments, providing access to sustainability data.
The outer circle, a digitally traceable wool supply chain, is covered by The Fiber Traceability Initiative. The inner arrows represent the product’s afterlife stages. These will also be digitally traceable in the future, promoting circular business models from farm to store and beyond.


“Traceability and transparency benefit stakeholders in the entire value chain. This project also serves as a springboard for brands preparing for upcoming legislation.”
Stina Behrens, Project Manager, Future Materials
The fashion industry produces 100 billion new garments annually. Estimates suggest that more than 50% of these garments are discarded within a year of production. The textile sector’s significant environmental footprint and its role in the “throwaway” culture are the reasons behind the EU’s focus on the textile industry and traceability.
Many consumers seek sustainable products but are hindered by limited access to credible information about sourcing, production, and environmental impact. Improved traceability systems, such as digital product passports (DPPs), aim to bridge this gap and reduce greenwashing, thus empowering consumers
to make informed choices. By 2030, all textile products within the EU will be required to have digital product passports. These passports will track details like material composition, carbon footprint, repairability, and end-of-life options, providing transparency across the supply chain.
In order to address the growing demand for transparency, and to prepare for the digital products passports, The Fiber Traceability Initiative was formed in 2023 as a collaboration between Axfoundation, Filippa K, GS1 Sweden, and VirtualRouteZ. It resulted in a beta version of a solution enabling a digitally traceable wool supply

Meet our partner
Karolin Catela, Product Specialist, GS1 Sweden
In what way are global standards important for value chain actors?
– GS1 global standards enable effective traceability and sustainability across the value chain through a common business language. The standards allow trading partners to easily collaborate and share information throughout the entire value chain.
What role do digital product passports play in sustainable development?
– Digital product passports could enhance traceability, circularity, and transparency in the textile industry throughout the product
chain. The QR code-based solution was applied to twelve wool garments for the Filippa K Autumn/Winter 2024 season.
With a simple scan, all stakeholders in the value chain – from suppliers to brands and customers – can access detailed information about the raw materials, the production journey, and the sustainability data of the final garment. The information is all in the QR code powered by GS1, including verified Responsible Wool Standard certification which validates farms based on animal welfare, environmental, and social aspects.
The scalability of the solution lies in its adaptable framework, which can be expanded to other materials, products, and brands, using standardized GS1 systems and an interoperable digital platform.
The traceability accessed through the Fiber Traceability Initiative provides many benefits to all stakeholders in the value chain. By providing insight into the origins of raw materials, brands can better understand sourcing practices while building stronger customer relationships. Also, transparency and traceability enable predictability. Instead of reserving fabric for an upcoming collection, the brand can reserve fibers for

lifecycle. By offering detailed information, a digital product passport promotes sustainability and circular practices. Its interoperability integrates value chain data, providing insights to stakeholders and fostering trust through increased transparency.
What are the takeaways from The Fiber Traceability Initiative?
– Through active participation in initiatives, pilots, and proof of concepts like The Fiber Traceability Initiative, we can encourage the use of the GS1 standard portfolio by collaborating with the industry.
several collections. This entails flexibility, and reduces waste. Furthermore, interoperability contributes to coordination and efficiency for suppliers, which in turn lowers costs and optimizes production.
The level of innovation and adaptation to EU regulations puts its partners at the forefront, providing them with competitive advantages. QR codes not only facilitate traceability but can also enable new business models, such as repair, resale, and circular consumption. In this project, Filippa K provides customer recommendations for care, repair, and resale through the QR code. In summary, the new generation of QR codes are powerful vehicles for changed consumer behaviors, customer loyalty and businesses’ transition to circular business models.
As part of the EU’s Circular Economy Action Plan, the textile industry has high potential for improving sustainability by reducing waste, extending product lifespans, and ensuring sustainable sourcing practices.
The Fiber Traceability Initiative assists companies in the shift towards circular economy models, where textiles are durable, repairable, and recyclable. The initiative also prepares for compliance with the EU’s textile strategy and the Ecodesign Directive, including the implementation of digital product passports.
With this beta version, the Fiber Traceability Initiative aims to inspire the global wool industry and invites fashion, interior, and other brands to join. Onwards, the project is participating in the Nordic Council of Ministers’ accelerator, Nordic Innovation, facilitated by Accenture. The accelerator will result in a playbook for circularity and data, as well as a policy brief.

Results
• Implementation of digital traceability throughout the entire wool value chain, from farm to store, using a QR code powered by GS1.
• Digital collection and sharing of data from all production stages, including Responsible Wool Standard (RWS) certification.
• Introduction of global standards (GS1) for product identification and labeling, promoting system interoperability.
• A solution based on the digital platform (VirtualRouteZ) that facilitates data collection and sharing across the supply chain.
• Increased transparency for consumers by providing information about the product’s journey and sustainability.
• Brand recommendations on care, repair and resell for each garment.
• Full traceability in Filippa K’s Autumn/ Winter 2024 merino wool collection.
Partners
The Initiative was formed by Filippa K, Axfoundation, GS1 Sweden and VirtualRouteZ. Enabling label supplier was Trimco. Wool suppliers who have participated and implemented the solution in the first phase are the sheep farms Coeja, 3GD, Gildenhuys, Loubser Koch, Grass Co., Bibbey (South Africa), the scouring facility Lemperiere (Bulgary), the spinning and washing facilities Tollegno and Millefilli (Italiy), and the garment manufacturer Trico Point (Romania). The Initiative welcomes more brands and suppliers in different industries to join.

The Fiber Traceability Initiative
To buying brands:
• Use QR code solutions and global standards to ensure product transparency and traceability.
• Adapt your operations to upcoming requirements for digital product passports to ensure compliance and competitiveness.
• Guide your customers to sustainable choices by making data available, whether it concerns the production or the product’s lifecycle (care, repair, resale).
To suppliers:
• Digitize and standardize administrative processes by implementing global standards (such as GS1) for data management.
• Upgrade your systems to support digital data collection and sharing throughout the value chain.
• Collaborate with progressive peers to gain competitive advantage.
To policy makers:
• Promote the use of global standards to ensure consistency in traceability and transparency.
• Develop policies that support circular business models and sustainable consumption in different industries.
To consumers:
• Support brands and products with transparent information on the production journey and recommendations for a prolonged lifecycle.
• Follow recommendations for care, repair, and resale for less waste and longer product life.
The Climate Education Tool

A free online learning space for SMEs
A tool that helps small and medium-sized companies to reduce GHG emissions.
A company’s value chain accounts for 65–95% of its total greenhouse gas emissions, making this the critical area of focus. To accelerate competence and incentives at the supplier level to reduce emissions, a free, science-based online tool was developed by Axfoundation with partners in 2022. Now available in six languages, the Climate Education Tool is integrated into the ImpactOS platform, enabling SMEs to measure and calculate their carbon emissions. Axfoundation’s role is to support the scaling.
Results
• By the end of 2024, the Climate Education Tool had reached around 20,000 users.
• The ImpactOS platform provides free carbon footprint calculator and global emission factors.
• New partnerships are helping scale the platform including the Climate Education Tool to SMEs worldwide.
Partners
Axel Johnson International, Dagab, The Swedish Trade Federation, Exponential Roadmap Initiative, ImpactOS by AskKauko.


Harvested Reed Cleans the sea and benefits the land
Reed beds have dramatically expanded along the Baltic Sea coast, causing bays and lakes to become overgrown. This increases the need to find innovative solutions for their use. Fortunately, reed is a sustainable material with great potential. When harvested, it can contribute to a healthier sea and be used for cultivation, packaging materials, and more.
The spread of reeds due to eutrophication harms biodiversity, water quality, and opportunities for recreation and leisure. However, reeds themselves are a sustainable material with important ecosystem functions. In addition to providing habitats for fish, birds, and insects, reeds absorb nutrients that would otherwise contribute to the eutrophication of the Baltic Sea.
By harvesting reed, nutrients from places where they cause problems are transferred to areas where they are beneficial, helping to store carbon in the process. Nitrogen and phosphorus are removed from the water and can instead serve as nutrient-rich material for cultivation, animal feed filler, and packaging material on land.
As a regenerative resource, the more we extract, the more we improve the health of the Baltic Sea ecosystem while building a regenerative value chain.
Partners
Various applications for harvested reed are being tested at Torsåker Farm and Lövsta north of Stockholm, in collaboration with Race for the Baltic and other stakeholders across different value chains. The tests include using reed as a replacement for peat in gardening soil, and as a mushroom substrate in collaboration with Stockholm Mushroom Farm. The project also evaluates the use of reed as horse feed at the 4H farm in Vallentuna and the extraction of cellulose for use in packaging and disposable items together with RAWS and RISE.
Axfoundation’s role in the project is to assist value chain actors with innovation work and contribute to a faster route to market for products such as packaging and mushroom substrate. In this work, Torsåker Farm is used as a test bed. We also provide feedback on tested products, such as those related to feed, soil health, and food packaging.
The project partners are Axfoundation, Race for the Baltic, Econova, Sjöutsikt, Lövsta Stuteri, RAWS, Kiteen Mato ja Multa Oy, and Stockholm Mushroom Farm.
Wool classification involves dividing wool into standardized classes based on its fiber diameter, length, cleanliness, color, and character.

The Swedish Wool Initiative
Industrial utilization of Swedish wool
Swedish sheep produce 1,000 tons of wool yearly, but over half is wasted. Since 2020, the Swedish Wool Initiative has enabled access to high-quality Swedish wool, aiming to improve resource efficiency and support circular products in construction, furniture, fashion, and more – toward zero wool waste.
Highlights
The Swedish Wool Standard: A national classification system for Swedish wool. The standard ensures the right quality of Swedish wool, from farm to sale.
A circular design guide for Swedish wool: A practical tool that helps companies use Swedish wool sustainably and circularly.
Collection Hub: Infrastructure and logistics solutions for a regional collection hub in the region of Dalarna serve as a model for other locations.
Product Development: Products based on circular design with Swedish wool as a raw material in the sectors of construction, furniture, fashion, outdoor, and home decor.



“With the right market conditions, efficient collection stations, and circular product development, there is potential to turn wool into a valuable resource across industries.”
Johan Sidenmark, Project Manager, Future Materials
Driven by business models that emphasize overproduction, overconsumption, and lowcost manufacturing, global demand for textiles is expected to increase by 150 % by 2050. As most textile fibers today are made from virgin, fossil-based synthetics or conventionally grown cotton, this leads to significant environmental challenges. In response, Swedish brands are increasingly focusing on regionally sourced, bio-based, and recyclable materials with circular potential.
Swedish wool is a promising material, yet more than 50% is discarded due to inadequate infrastructure for collection, lack of standardized quality assurance, and classification of wool. Consequently, Swedish brands import refined wool from various parts of the world, often with a higher environmental footprint and produced with lower animal welfare standards than Swedish wool.
Scaling up The Swedish Wool Initiative builds upon the lessons learned from its initial
phase. The focus is on enabling Swedish industries and suppliers in construction, furniture, fashion, outdoor, and home decor to easily access quality and competitive Swedish wool raw materials. The initiative also aims to create conditions for sheep farmers and shearers to receive a fair price for their Swedish wool, thereby stimulating wool collection.
Together with the project’s academic partners and expert group, solutions based on both research and practical experience from The Swedish Wool Initiative project are being scaled up and disseminated in a real environment, both regionally in Dalarna and nationally in Sweden, together with Arena Svensk Ull.
The project is based on the industry’s need to use locally produced raw materials to design circular products. This results in a resource-efficient and circular value chain where all Swedish wool is used to its highest potential.

Results

• By utilizing a renewable and regionally produced raw material for textile manufacturing, the project contributes to the transition to a circular industry, while also repurposing a waste stream that would otherwise be incinerated or discarded.
• Partners in The Swedish Wool Initiative used about 4.5 tons of Swedish wool in 2020, and 60 tons by 2024 .
• There are now commercially viable products in the fashion and outdoor sectors. The project continues to explore applications in new sectors such as furniture and home decor, construction, the automotive industry, and garden products.
• A circular design guide for Swedish wool has been developed by Science Park Borås, helping companies to use the right wool fibers for the right applications.
• Several innovative products have been developed based on circular design principles – ranging from knitted sweaters to woven wool suits, wool blankets, and backpacks stuffed with Swedish wool that were previously discarded. Additionally, a yarn has been
Partners
developed based on Swedish wool that would not normally be accepted in the spinning process due to a high amount of organic material.
• The Swedish Wool Standard simplifies trading with both high- and low-grades of Swedish wool, opening up entirely new market opportunities.
• A sustainability analysis of Swedish wool has been conducted by IVL Swedish Environmental Institute, indicating that Swedish wool can have a lower climate impact and more positive effects compared to wool production in other countries.
• Wool collection is currently underway in Dalarna, which will be used to create prototypes. The wool will be classified using The Swedish Wool Standard. Fabrics like tweed and loden will be produced, and new yarns are being developed for products such as rugs and base layers.
• The Swedish Wool Initiative, backed by a Vinnova Impact Innovation grant, will scale up with a pre-study on establishing a textile hub at Holma-Helsingland AB, with a capacity to collect and process 300 tons of wool.
The Swedish Wool Initiative is a broad collaboration with Axfoundation as project lead. Among the partners are Arena Svensk Ull, CTH Ericson, Dalarnas fåravelsförening, Dalarna Science Park, Filippa K, Fjällräven, Houdini, Högskolan Dalarna, Insjöns väveri, Klippan, Röyk, Science Park Borås, Sätergläntan, Tiger of Sweden, Ullkontoret, Verk, Väveriet i Bollnäs, Wool Rebel, Wålstedts Ullspinneri, and Åddebo ull. The project is partially funded by Vinnova and Region Dalarna.
Wool suit by Tiger of Sweden. A course in wool classification in Rättvik.

Meet our partners
Simon Anund, Founder and Creative Director at Verk.

– Verk produces sustainable furniture using domestic raw materials. The Swedish Wool Initiative helps us to make use of Swedish wool. For example, in 2023, at Möbelmässan, Verk presented an all-Swedish wool textile, designed by Ingegerd Råman. Axfoundation and the Swedish Wool Initiative supported the showroom and contributed through various lectures and panels.
– When we launched Verk in 2021, it was reported that 70% of all Swedish sheep’s wool was either burned or buried. Today, that figure has dropped to around 50% – a giant step in the right direction, though still far from ideal. Regardless, it’s a sign that interest in Swedish wool is continually growing, says Simon Anund.
– The next step for Verk and The Swedish Wool Initiative is to conduct a life cycle analysis on Swedish wool. That’s very exciting, and I can’t wait.

Charlotte De Besche and Helena Holmquist, Founders of Wool Rebel.
– Thanks to the project, we have received excellent support in experimenting with the wool in new ways, including valuable connections and expertise from the wool industry.
– The biggest challenge is producing our insulation on a suitable scale. Either the carding mills are too small to handle the volume we need, or they are too large, requiring us to process several tons of wool, which becomes both costly and results in large inventories.

– The advantages of The Swedish Wool Initiative are that we collaborate and share our knowledge! It’s also about raising awareness of Swedish wool and showcasing its many uses, so we can stimulate local trade.
Wool Rebel tests wool covers for raised beds at Torsåker Farm.
Backpack by Fjällräven.
Timeline The Swedish Wool
2018 The project Circular Wool Clothing took place, where companies such as Filippa K, Tiger, of Sweden, Röyk, and Fjällräven participated. The sweater “Elin” was produced by Filippa K.
2020 Funding was sought for The Swedish Wool Initiative.
2021 The Swedish Wool Initiative 1.0 was established.
2022 A rena Svensk Ull was initiated.


2023 The Swedish Wool Standard was launched. Tiger of Sweden designs and produces a suit in Swedish wool. K lippan Wool Factory produces Swedish worsted yarn from wool that was previously discarded.
2024 The Design Guide was launched. The Swedish Wool Initiative participated in the Stockholm International Fashion Fair.
The Swedish Wool Initiative 2.0 was launched. Prototypes with Swedish wool were made.

Jacket fill by Fjällräven.
Sofa by Verk.
Initiative





Braided Swedish Wool Sweater by Filippa K.
Yarn by Klippan.
The wool is “picked” at Wålstedts Ullspinneri, Dala Floda

Returnable
A circular system for reusable grocery bags
In 2023, 574 million single-use plastic and paper bags were sold in Sweden’s grocery industry. Stacked, they would reach 190 km, the distance from Stockholm to Örebro. The rise in grocery deliveries has spiked bag use – bags that are rarely reused or recycled. To address this challenge, the Returnable project works for an industry-wide solution for a circular system of reusable grocery bags.
Highlights
System Shift Iteration: The project has developed reusable bag prototypes and a reverse logistics system with digital traceability, deposit systems, cleaning, and shared logistics for reuse and eventual recycling.
Industry-Wide Collaboration: Stakeholders across the grocery sector have united through the project, with a common goal to develop a circular solution for reusable grocery bags.
Encouraging Customer Trials: Initial customer tests 2024 provided valuable insights into the system’s design, and overall user experience. These findings are shaping the next iteration of the bag and system prototype, set for large-scale piloting in 2025/2026.


“Beyond addressing customer frustrations with single-use bags, we hope that this new reuseable bag system can facilitate circular flows on a larger scale in other industries.”
Amelie Silfverstolpe, Project Manager, Future Materials
In 2023, Swedish grocery stores, both online and physical, sold 574 million single-use plastic and paper bags – often used just once, leading to significant resource waste. In online grocery deliveries, the overuse of delivery bags not only frustrates customers but also fuels this waste. Current sustainability solutions focus primarily on recycling rather than minimizing resource use through reuse.
Consumers are becoming increasingly tired of piles of discarded bags, and the demand for reusable alternatives is growing. Both the EU and Swedish governments are also quickly enacting laws to promote reusable packaging. Most significant for this project is the EU’s PPWR (Packaging and Packaging Waste Regulation) which regulates what
kind of packaging can be placed on the EU market. It stipulates that at least 40% of reusable packaging should be used by 2030 and at least 70% by 2040.
The Returnable project addresses this challenge – and opportunity – by developing an industry-wide, sustainable circular system for reusable grocery bags. The solution involves un-branded reusable delivery bags shared among industry partners, designed for repeated use by consumers.
Spearheaded by Axfoundation and Chalmers Industriteknik, the initiative brings together key actors in the grocery sector to co-create a joint circular system featuring a deposit-based “borrow bag”. The project
A schematic flow of the reusable bag’s circular journey.

has developed prototypes for reusable grocery bags and mapped out a reverse logistics system, including traceability, deposit systems, cleaning processes, and a shared logistics network to ensure that bags are reused and, when finally necessary, recycled.
Axfoundation’s ambition is to help the industry and its customers move from a linear to a circular economy. Initial calculations
Bag Facts
suggest that reusable bags could reduce CO2 emissions by up to 58% compared to single-use paper bags.
The goal is to transition e-commerce to reusable bags by 2026/27, potentially saving more than 500,000 kg of CO2. Expanding the solution to retail could further amplify these savings and encourage consumers to adopt more circular habits, one important piece in the necessary norm shift.
• Reusable bags could reduce CO2 emissions by 58% compared to single-use paper bags.
• In 2020, the Swedish government adopted a milestone target to increase the share of reusable packaging on the market by at least 20% from 2022 to 2026, and by at least 30% from 2022 to 2030. Also, the Swedish law on Producer Responsibility (Producentansvar) requires companies to report the number of rotations their reusable packaging goes through in order to meet the milestone target.
• The EU’s Packaging and Packaging Waste Regulation (PPWR) goes further (and overrules the Swedish milestone target). It sets guidelines for the types of packaging allowed on the EU market. It mandates that at least 40% of transport packaging must be reusable by 2030, increasing to at least 70% by 2040.
• A significant norm shift is required for consumers to transition from using single-use plastic and paper bags to reusable bags. Awareness, convenience, and habit formation are some of the key elements.

Meet our partner
Åsa Domeij, Head of Environment and Social Responsibility at Axfood.

Results
• Developing an industry-wide circular solution for reusable grocery bags is a complex, time-intensive process. In collaboration with partners, Axfoundation has conducted an in-depth analysis of the disposable packaging system at a macro level, carrying out a thorough sustainability assessment and mapping the needs of both the industry and consumers.
• The project has established and refined a comprehensive system hypothesis, iterated a premium reusable bag made from 100% recycled PP, developed a robust traceability model utilizing QR and RFID codes, and completed an extensive customer analysis alongside a detailed business model.
• Four critical components have been identified as essential to address: the bag, the deposit system, the cleaning process, and the reverse logistics.
• Two pilot tests, conducted over six weeks with 200 e-commerce customers, yielded exceptionally positive results.
• A business model has been developed, encompassing investment forecasts and a break-even analysis for both the overall system and individual retailers.
• The next phase will involve a largescale pilot, where all food retailers in a designated city will test the circular system, to test a fully operational incentive program and a reverse logistics scheme.
– Switching to reuse rather than relying solely on material recycling is an important step in the circular economy. The Returnable bag also offers practical benefits for customers, eliminating the accumulation of bags at home. Additionally, the project serves as a solid preparation for the industry ahead of the upcoming EU legislation on packaging, PPWR.
– An industry-wide solution provides greater benefits for everyone, especially customers. You can compare it to the deposit system for beverages. Imagine how inconvenient it would be if every chain had its own system! Now, you can return your bottle anywhere, no matter where you bought it. The same applies to SRS crates, also an industry-wide system. It’s practical and resource-efficient.
– The implementation phase involves complex changes that must take place across the entire food industry, both in physical stores and e-commerce. The introduction of legislation mandating reusable packaging will help, just as it did with bottle deposits. The reusable bag is timely and represents a development we need to move forward.
Partners
The Returnable project is led by Axfoundation, partly in collaboration with Chalmers Industriteknik, and brings together partners from Coop, ICA, Hemköp, Lidl, Willys, The Swedish Food Retailers Federation, and Svenska Retursystem. It is carried out in cooperation with the service design and UX agency Antrop, the design agency Boid, Stena Circular Consulting, and GS1 Sweden.
Does this mess look familiar? No more stacks of bags with the Returnable system.

“We aim to develop solutions that benefit all parties throughout the system.”
Johanna Olofsson Behrman, Project Manager, Future Materials

CircSolar
A circular solution for solar panels
By 2050, solar panel waste volumes could exceed 100 million tons globally, valued at 150 billion dollars. There is significant potential for repair, reuse, upgrading, and recycling throughout the lifecycle of the panels. The CircSolar project is developing a proposal for a new national system to manage solar panels in a circular manner.
Solar energy is among the fastest-growing energy sources globally. It offers a clean, renewable solution with significant environmental and climate benefits but also faces challenges.
Currently, no circular system exists for reuse or fully managing materials in worn-out and discarded solar panels.
Without action, society could face over 100 million tons of solar panel waste globally by 2050. Implementing a circular approach is crucial for ensuring the long-term sustainability of solar energy.
The CircSolar project unites stakeholders across the value chain to propose a system for sustainable, financially viable solar panel management.
The project aims for a circular system ensuring compliance with future legal requirements, securing access to recycled materials, reducing reliance on virgin natural resources, and strengthening competitiveness in the Swedish and European solar energy sectors.
The project started in 2023, with its first phase centered on a system analysis led by KTH Royal Institute of Technology.
Partners El-kretsen, KTH, REMONDIS, Stena Recycling, and Svea Solar. The reference group includes AxSol, INGKA Group (IKEA), Nordcell, SolTech Energy, Sonat, The Sunshine Fund, the Swedish Solar Energy Association, Alight, Sesol, and Nätverket för Solparker. The project is supported by Vinnova.

YeastGuard
A living material that reduces food waste
Can living materials slow down decomposition processes? To answer the question, researchers and experts unite to develop a new nature-based solution, an innovative living material using yeast to prevent mold, cut food waste and bolster food system resilience.
Today, mold poses a significant threat to fresh fruit and vegetables, resulting in massive global food waste. Efficient, sustainable, and safe methods to combat molds are largely lacking.
Up to 60% of harvested fruits and vegetables can go to waste globally due to e.g. mold growth, driving an urgent need for innovative solutions.
The project ‘YeastGuard: Yeast-Powered Solutions to Combat Food Waste’ aims to develop a new living material where yeasts produce natural substances, called biogenic
Partners
volatiles, preventing mold from spoiling harvested fruits and vegetables. With Torsåker Farm as test arena, Axfoundation gathers industry partners to incorporate the market perspectives in the project.
The best-performing yeast in 3D-printed material prototypes will be tested, as well as the effect of these on fresh produce inoculated with molds in closed packages.
The YeastGuard project will also explore if yeasts that are naturally found in Swedish Honey can be used for additional applications in the food industry.
The cross-disciplinary project brings together researchers and experts in microbiology and biotechnology at Chalmers University of Technology, material science at Aalto University, and 3D food printing and food safety at RISE. The project is financed by Formas.
Courage to Fail
In all projects, we encounter obstacles that require us to rethink and adapt our approach. It’s a constant part of our work, helping us to continuously improve and learn from each project.

Plastic Progress Tools
One solution didn’t fit all plastics
Axfoundation aimed to create a standard for companies to map and address plastic use, developing a practical methodology and a digital tool prototype. However, creating a universal tool for compiling and analyzing plastics data proved more complex than expected.
The world’s use of plastic is rapidly increasing. At the current pace, global plastic production and emissions are expected to double by 2050. The material value of plastics is lost by as much as 95% after just one use cycle. Approximately 98% of all plastics are virgin, and only 1% is recycled to the equivalent quality. If we fail to address these issues,
projections from the World Economic Forum and the Ellen MacArthur Foundation indicate that, by 2050, the oceans could contain more plastic, by weight, than fish.
Plastic overconsumption and mismanagement of plastic waste is a growing menace, causing pollution, landfills to overflow, choking
“Honestly, it’s a bit overwhelming at times to think of how we can – and must – make all this data digitally available in just a few years”.
Hanna Hobohm Skoog, Programme Director, Future Materials
rivers, and threatening marine ecosystems. The EU is acting against this plastic overconsumption and pollution with several legislative frameworks, including the Circular Economy Action Plan, the Single-Use Plastics Directive, and the Plastic Bags Directive, to name a few.
Companies are struggling to adapt their businesses to these new legislations, while simultaneously trying to understand and act on their own plastics use. Few have the necessary methods and tools to properly map their current use.
To address this challenge, the Plastics Progress Tools initiative was launched in 2020 to find a standard for how companies can map and act on their use of plastics. Together with stakeholders from different value chains and sectors, the project aimed to develop a practical and standardized methodology and digital tool. The purpose was to support companies with a unified approach to measuring plastics, providing a basis for strategic prioritization and decision-making.
The methodology was designed to describe how companies can take a step-bystep approach to setting goals and key
Lessons learned
performance indicators (KPIs), collecting data, and analyzing the results. A list of definitions was developed to create a common language around some of the complex terms related to plastics. The methodology and list of definitions are currently available in Swedish.
However, along the way, Axfoundation discovered that developing a generic digital tool for compiling and analyzing plastics data was more difficult than first anticipated.
Plastics are found everywhere and in countless variants and shapes, making it even more challenging for companies to map and measure. Lack of upstream data from suppliers, the complexity of data sets and alignment, the integration with current data systems, and challenges in harmonizing how and what to measure were some of the obstacles.
Due to these challenges, Axfoundation didn’t succeed in finding a scalable and standardized solution. Nevertheless, the focus on measuring plastics in the EU has increased. The market has responded by developing company specific and integrated solutions for packaging and product data in existing data systems – a development that Axfoundation warmly welcomes.
• A xfoundation believes in industry-wide solutions, but the inherent nature of plastics made collaboration difficult. Its countless varieties and forms made the development of a generic tool more difficult than anticipated.
• The lack of upstream data from suppliers was challenging; however, it was not a surprise. Here, upcoming EU regulations on digital product passports will hopefully be helpful to set a standard for how to structure, standardize, and compile plastic data. Axfoundation is continuing to work with transparency in supply chains and supporting companies to share structured, traceable product and material information.

Industrial Hemp
Too few seeds and too many weeds
Nutritious, carbon-sequestering, and fast-growing – hemp is a plant with numerous benefits. However, Axfoundation’s efforts to grow hemp for fiber and seeds faced several challenges: too much rain, too much drought, and excessive weed growth resulted in a small harvest.
Hemp is an ancient crop that has been used for producing ropes, sacks, sails, and paper. The hemp seed and its oil can be used as food. Once established, the crop competes effectively against weeds due to its robust growth. Due to its narcotic properties, hemp cultivation was banned
in Sweden in 1974. However, since 2003, it has once again been permitted to grow industrial hemp in Sweden. The industrial hemp cultivated at northern latitudes cannot be used for drug production. Hemp cultivation can help solve many of the sustainability challenges facing agriculture
“We believe in hemp as a crop, and it’s important to keep trying. We haven’t given up, even though we had two bad years. Growing hemp takes practice.”
Maria Lundesjö, Project Manager, Future Food
today. Since the plant is fast-growing and has dense foliage, it is difficult for nearby weeds to grow and thrive, thus eliminating the use of pesticides.
The hemp plant’s deep taproot helps improve the nutrient uptake from the soil and makes the crop resistant to both drought and water stress. Hemp also sequesters 10-15 times more carbon dioxide than cereals. It has the potential to be used as a raw material in food, but it is also seen as an interesting material for the construction and textile sectors.
Given all these potentials and benefits, Axfoundation saw an opportunity to grow fiber hemp and seed hemp, making use of the fibers for materials and the seeds as a raw material in innovative, sustainable, flavorsome, and healthy food products. A small-scale cultivation test of EU-certified industrial hemp has been conducted at Torsåker Farm since 2022.
However, the seeds were sown too sparsely, which prevented us from fully succeeding. The ambition to use the fibers in tests at Borås Textile College to evaluate
Lessons learned
the conditions for using the crop’s fiber was not realized. The hemp seeds were harvested and dried at Torsåker Farm, then the seeds were sorted, pressed, and analyzed within the framework of the Vinnova-funded project Sustainable Hemp Innovations.
In collaboration with several actors, Axfoundation investigated which foods hemp seed and hemp seed cake could be used for. To conclude, growing hemp in our latitudes requires practice and the right type of machinery.
Despite experiencing poor harvest two years in a row, it is important to keep trying. We believe in hemp as a crop and remain humble in the face of the external forces we are dealing with.
Somehow, the story concludes with a happy ending. The fiber hemp plants significantly improved the soil quality. The compact soil became looser due to the long roots.
The wheat grown in the same place today is thriving. In addition, the tenant farmer at Torsåker Farm was inspired by the tests and is continuing to grow hemp in the area.
• In Sweden, the infrastructure around hemp cultivation is undeveloped, and there is a lack of in-depth knowledge regarding the required specific steps to refine and process hemp fiber as well as hemp seed from different variations.
• The hemp plant has long been linked to the production of marijuana and illegal substances. A hemp field might give the wrong associations to people passing by. To avoid misconceptions, Axfoundation put explanatory signs around the fields.
• In the central and northern parts of Sweden, the growing season for seed hemp is challenging. Perhaps there are other varieties that are better suited for this region? In any case, hemp is an excellent preceding crop for wheat.


Photos
Mats Paulsson: Cover, p. 1 (food), 2–3, 4–5, 12–13, 16 (fields), 20–21, 41 (tent)
Peter Jönsson: p. 1 (materials), 6–9, 52–53
Minna Berg: p. 42, 50, 54, 70
Linda Prieditis: p. 18 (lamp), 19 (kitchen), 45 (kernza), 74
Pelle Jansson: p. 10, 71 (bags), 80, 81–82,
Evelyn Del Carmen: p. 56, 58–59
Ecopelag: p. 34
Ragn-Sells: p. 36
Thomas Jansson: p. 67 (sweater)
Govt Office/Josefine Stenersen: p. 14–15
Govt Office/Ninni Andersson: p. 30 (portrait)
©Nobel Prize Outreach/Dan Lepp: p. 26 (porridge)
iStock/Narvikk: p. 28
iStock/hisartwork: p. 29
iStock/lkpgfoto: p. 30 (cows)
iStock/Hydromet: p. 30 (people)
Unsplash/Arisa Chattasa: p. 35 (chicken)
iStock/ JohnAlexander: p. 38
iStock/RundMorijn: p. 39
iStock/Bilanol: p. 72
iStock/TowfiquAhamed: p. 73
All other photos: Axfoundation
Illustrations
Mathias Forslund/Design54: p. 31, 57, 69
Mathias Forslund/Design54 & Feri Fazeli: p. 18 (map)
Pelle Jansson: p. 11
Torsåker Digital Museum: p. 19 (castle)

The Team

The Board

The Team
Previous spread, top row, from left to right:
• Maria Lundesjö, Farmer and PhD in Meat Science
• Emilia Samuelsson, Researcher and artist
• Carolina Lindfors, Digital communication’s wizard and vintage lover
• Johanna Behrman, Circular economy- and reuse enthusiast
• Christian Sjöland, Business- and cheese lover
• Sofia Lundvall, Meal echologist and ghosthunter
• Hanna Hobohm Skoog, Pragmatic idealist and West coast patriot
• Johanna Westberg, Location Coordinator and snowboarder
• Johan Sidenmark, Biologist and entrepreneur
• Anna Henning Moberg, Creative ingredient nerd
Middle row:
• Claes Grännsjö, Curious chef dreaming of a woodfired oven
• Marit Wirén Toll, Horticulturist and farming factotum
• Anneli Lundqvist, Creative coordinator and craftsperson
• Stina Behrens, Circular systems innovator with a digital edge
• Amelie Silfverstolpe, Problem solver and sailor
• Fredrik Karlsson, Vernacular food artisan
• Marie Wallin, Site Manager, sommelier and doula
• Maria Smith, Business-minded leader with a Northern calm
Bottom row:
• Madeleine Linins Mörner, Creative strategist with a rebellious streak
• Veronica Öhrvik, Camper and PhD in Food Science
• Safira Blom, Service Host and jewellery designer
• Viveka Risberg, Communicator and songwriter
Missing from the photo: Linda Andersson, Director of Communications and embroiderer.
The
Board
Above: Christina Lindbäck, Mikaela Valtersson, Alexandra Mörner, Antonia Ax:son Johnson, David Salsbäck, and Lisen Schultz.
Missing from the photo: Einar Bodström.
Subscribe to Axfoundation’s newsletter.
What goes around comes around
The circular story behind the cover
Front
By harvesting reed, nitrogen and phosphorus are removed from over-fertilized waters. On land, reed can be utilized in various ways, such as straw, packaging material, mushroom substrate, mulch, animal feed filler, and for improving soil quality. Axfoundation is testing several applications for Swedish reed. Read more about projects within the program area Future Materials on page 52.
Back
Spent grains mixed with waste streams from the food industry are used to feed Black soldier fly larvae. These insects become feed ingredients for poultry and laying hens, while the waste streams are repurposed to feed new insects, produce fish feed, and eventually create delicious food. Read more about projects within the program area Future Food on page 20.
